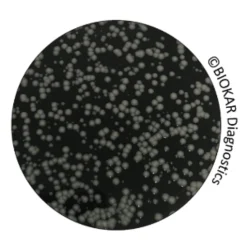
GVPC AGAR FOR LEGIONELLA
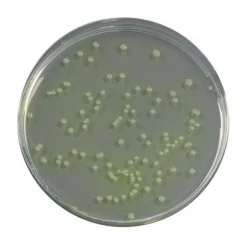
PENICILLIN VÀ PIMARICIN AGAR (PPA)
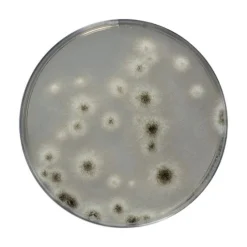
SABOURAUD DEXTROSE CHLORAMPHENICOL AGAR (SDCA)

ACETAMIDE BROTH
Acetamide broth tạo thành một trong những môi trường xác nhận (kết hợp với thạch King B) được sử dụng trong phân tích nước để phát hiện và định lượng Pseudomonas aeruginosa. Người ta thường chấp nhận rằng nước khoáng thiên nhiên, nước suối và nước đóng chai không được chứa mầm bệnh cơ hội này. Vì lý do sức khỏe cộng đồng, các loại nước khác như bể bơi và nước uống được cũng có thể được kiểm tra sự hiện diện của Pseudomonas aeruginosa.
Thành phần môi trường theo tiêu chuẩn NF EN ISO 16266 & NF T90-421.
Quy cách đóng gói:
Môi trường pha sẵn
BM09508 – 7 ống x 5 mL
ACID HYDROLYSATE OF CASEIN
Acid Hydrolysate of Casein là thành phần trong môi trường nuôi cấy dùng trong kiểm nghiệm vi sinh cũng như các nghiên cứu về tính kháng kháng sinh, kháng Sulfamides của vi khuẩn. Nó có trong thành phần của môi trường Mueller-Hinton Agar.
Acid Hydrolysate of Casein không chứa Tryptophan, Cystine và Vitamins
Quy cách đóng gói:
Môi trường bột khô
A1404HA – Chai 500 g
ALKALINE SALINE PEPTONE WATER (ASPW)
Alkaline Saline Pepton Water (ASPW) được sử dụng như môi trường tăng sinh chọn lọc đầu tiên và thứ 2 cho việc phát hiện Vibrio spp. trong các sản phẩm thực phẩm cho người và động vật cũng như các mẫu môi trường.
Thành phần môi trường theo tiêu chuẩn vi sinh thực phẩm NF EN ISO 21872-1.
Quy cách đóng gói:
Môi trường bột khô
BK219HA – Chai 500 g
AZIDE DEXTROSE BROTH
Azide Dextrose Broth được sử dụng để định lượng enterococci trong nước uống, thực phẩm đông lạnh và các sản phẩm thực phẩm khác bằng phương pháp đếm số có xác suất.
Quy cách đóng gói:
Môi trường bột khô:
BK060HA – Chai 500g
BACILLUS CEREUS AGAR BASE
Bacillus cereus Agar được sử dụng để phát hiện và định lượng số bào tử, tế bào sinh dưỡng của vi khuẩn Bacillus cereus trong các sản phẩm thực phẩm. Nó được sử dụng để định lượng Bacillus cereus giả định ở 30°C của theo tiêu chuẩn (NF ENISO 7932). Nó cũng được sử dụng trong các phương pháp phát hiện số lượng nhỏ theo NF EN ISO 21871.
Thành phần chính tương ứng với MYP agar (mannitol, egg yolk emulsion, polymyxin agar) theo tiêu chuẩn NF EN ISO 7932 và NF EN ISO 21871.
Quy cách đóng gói:
Môi trường đổ sẳn:
BM03808 – 20 đĩa (Ø 90 mm)
BM19908 – 200 đĩa (Ø 90 mm)
Môi trường bột khô ( không có egg yolk và Polymyxin B):
BK116HA – Chai 500g
Egg yolk emulsion tiệt trùng:
BS06608 – 10 ống x 50mL
Chất bổ sung chọn lọc Polymyxin B:
BS00708 – 10 lọ
Egg yolk emulsion tiệt trùng với Polymyxin B :
BS05508 – 10 ống x 50mL
BACTERIOLOGICAL AGAR TYPE A
Bacteriological Agar đóng vai trò là chất cố định trong việc chuẩn bị môi trường nuôi cấy rắn ở nồng độ khoảng 12 và 20g/L.
Quy cách đóng gói:
A1010HA – Chai 500 g
A1010GC – Thùng 5 kg
BACTERIOLOGICAL AGAR TYPE E
Bacteriological Agar đóng vai trò là chất cố định trong việc chuẩn bị môi trường nuôi cấy rắn ở nồng độ khoảng 12 và 20g/L.
Quy cách đóng gói:
A1012HA – Chai 500 g
A1012GC – Thùng 5 kg
BACTERIOLOGICAL MALT EXTRACT
Malt extract chủ yếu trong nuôi cấy và đếm nấm men, nấm mốc trong trong môi trường chiết xuất malt. Nó có lợi cho sự hình thành bào tử của nấm mốc như Aspergillus và Penicillium. Bởi vì nó có hàm lượng carbohydrate cao, malt extract không nên đun quá nóng, vì môi trường nuôi cấy sẽ biến thành màu nâu.
Quy cách đóng gói:
A1101HA – Chai 500 g
A1101GC – Thùng 5 kg
BACTERIOLOGICAL MEAT EXTRACT
Kết hợp với các pepton có nguồn gốc khác nhau, Bacteriological Meat Extract là chất dinh dưỡng bổ sung tuyệt vời cho việc chuẩn bị một loạt các môi trường nuôi cấy. Nó thường được sử dụng ở nồng độ từ 0.2 đến 1%.
Quy cách đóng gói:
Môi trường bột khô
A1710HA – Chai 500 g
BAIRD PARKER AGAR WITH EGG YOLK TELLURITE
Baird Parker Agar với Egg Yolk Tellurite là một môi trường chọn lọc để phát hiện và đếm Staphylococci dương tính coagulas( Staphylococcus aureus và các loài khác) trong các mẫu sinh học, dược phẩm, mỹ phẩm, thực phẩm và nước.
Thành phần theo tiêu chuẩn NF EN ISO 6888-1, NF EN ISO 6888-3 và NF V08-057-1.
Quy cách đóng gói:
Môi trường bột khô:
BK055HA – Chai 500g
BK055GC- Thùng 5kg
Egg yolk emulsion with Potassium tellurite (Egg yolk 20%)
BS06008 – 50mLx 10 lọ
BS03608 – 900mL/ chai
Chất bổ sung Sulfamethazine 25 mg
BS02808 – 10 lọ, mỗi lọ bổ sung cho 500ml môi trường cơ bản
Môi trường đổ đĩa sẵn (phi 90mm)
BM01808 – 20 đĩa
BM09108 – 120 đĩa.
Baird-Parker RPF Agar
ĐẾM VÀ KHẲNG ĐỊNH STAPHYLOCOCCI DƯƠNG TÍNH COAGULASE
Baird Parker RPF (RPF = Rabbit Plasma Fibrinogen) là một môi trường chọn lọc để phát hiện và đếm trực tiếp Staphylococci dương tính coagulase trong thực phẩm và nước mà không cần phải khẳng định lại.
Thành phần theo tiêu chuẩn NF EN ISO 6888-2.
BCP DEXTROSE TRYPTONE AGAR
BCP Dextrose Tryptone Agar (còn được gọi là BCP Glucose agar) được sử dụng để đếm các bào tử vi khuẩn Mesophilic và vi khuẩn ưa nhiệt hiếu khí (đặc biệt là vi khuẩn Bacillus stearothermophilus, tạo vị chua) trong nguyên liệu và các thành phần sử dụng trong các sản phẩm đóng hộp(pH > 4.5). Nó cũng được dùng để định lượng mẫu bề mặt và nước dùng trong thực phẩm đóng hộp.
Thành phần môi trường theo tiêu chuẩn NF V08-602.
Quy cách đóng gói:
Môi trường pha sẵn:
BM16808 – 10x 200 mL
Môi trường bột khô:
BK042HA – Chai 500g
BCYE AGAR CÓ CYSTEINE VÀ BCYE AGAR KHÔNG CÓ CYSTEINE
BCYE agar có và không có cysteine là môi trường dùng để khẳng định Legionella.
Chúng được dùng để xác nhận các khuẩn lạc thu được trên thạch GVPC, bản thân nó cũng được sử dụng để định lượng và phân lập các loài Legionella trong nước và trong các mẫu khác dễ nhiễm vi khuẩn.
BCYE agar có cysteine:
BM07208 – 20 Đĩa Petri Ø 90 mm
BCYE agar không có cysteine:
BM07308 – 20 Đĩa Petri Ø 90 mm
BEA AGAR (BILE, ESCULIN & AZIDE)
Bile Esculin azide Agar (BEA Agar) là một môi trường chọn lọc dùng để phân lập và định lượng enterococci trong thực phẩm và các sản phẩm dược phẩm. Nó cũng được sử dụng để định lượng enterococci trong thức ăn chăn nuôi.
Thành phần môi trường theo tiêu chuẩn NF EN ISO 7899-2 và NF T90-421, để khẳng định enterococci trong nước và trong nước hồ bơi.
Meat-liver Glucose Agar được sử dụng để định lượng các bào tử vi khuẩn kị khí sinh sulfite trong nước. Thành phần môi trường cũng đáp ứng tiêu chuẩn NF T90-415.
Quy cách đóng gói:
Môi trường chuẩn bị sẳn
BM10408 – 10 ống x 100ml
Môi trường bột khô
BK158HA- Chai 500 g
BISMUTH SULFITE AGAR (ISO 6579-1)
Bismuth Sulfite Agar ISO 6579-1 là môi trường chọn lọc được sử dụng để phân lập Salmonella trong nước, sản phẩm sữa và các sản phẩm thực phẩm khác.
Môi trường này đặc biệt được sử dụng để phát hiện các phân loài Salmonella enterica enterica serovars Typhi và Paratyphi trong thức ăn cho người và cho động vật ăn, mẫu môi trường và mẫu từ giai đoạn sản xuất ban đầu.
Bismuth Sulfite Agar có thể được sử dụng trong các phương pháp chuẩn hóa để phát hiện Salmonella làm môi trường phân lập thứ hai.
Thành phần môi trường theo tiêu chuẩn NF EN ISO 6579-1.
Quy cách đóng gói:
Môi trường bột khô
BK223HA – Chai 500 g
BLOOD AGAR (BASE)
Blood Agar ( Base) được sử dụng làm chất nền để bổ sung máu, điều chế từ các nguyên liệu không bị hóa nâu. Blood Agar ( Base) được thiết kế đặc biệt nhằm phát hiện các phản ứng tán huyết beta, tạo điều kiện cho sự phát triển của vi khuẩn hiếu khí và kỵ khí đặc biệt khó tính.
Môi trường còn được sử dụng để thử nghiệm tán huyết trên các khuẩn lạc giả định Bacillus cereus, theo tiêu chuẩn ISO 21871.
Quy cách đóng gói:
Môi trường bột khô ( không có Novobiocin ):
BK028HA – Chai 500g
BOUILLON EUGON LT 100 BROTH
Eugon LT 100 Broth được sử dụng như một chất pha loãng trung hòa, môi trường tăng sinh vi sinh vật trong mỹ phẩm có và không có chất bảo quản.
Thành phần môi trường đáp ứng tất cả các tiêu chuẩn về mỹ phẩm: NF EN ISO 18416; NF EN ISO 21149; NF EN ISO 21150; NF EN ISO 22717; NF EN ISO 22718; NF EN ISO 16212; NF EN ISO 18415; NF EN ISO 11930.
BRAIN HEART AGAR
Brain-Heart Agar là một môi trường nuôi cấy được nhiều loại vi sinh vật khác nhau bao gồm cả nấm men nấm mốc. Sau khi thêm máu cừu, môi trường này có thể nuôi cấy nhiều vi khuẩn khó tính trong lĩnh vực thú y. Khi thêm gentamicin và chloramphenicol, môi trường chọn lọc phù hợp để nuôi cấy các loại nấm gây bệnh từ các mẫu vi khuẩn và nấm mốc hoại sinh bị nhiễm nặng. Môi trường không phù hợp với đặc tính tán huyết vì hàm lượng đường cao.
Quy cách đóng gói:
Môi trường bột khô ( không có Novobiocin ):
BK029HA – Chai 500g
BRAIN HEART BROTH (BHB)
Brain-Heart Broth (BHB) là một môi trường dinh dưỡng đệm được sử dụng để nuôi cấy một loạt các vi khuẩn kị khí và hiếu khí bao gồm nấm men và nấm mốc. Môi trường này thích hợp cho việc phát hiện staphylocoagulase.
Thành phần của môi trường tương ứng với công thức được mô tả trong hướng dẫn NF EN ISO 6888-1, NF EN ISO 6888-3 & NF V08-057-1 trong vi sinh thực phẩm.
Quy cách đóng gói:
Môi trường bột khô:
BK015HA- Chai 500g
BRILLIANT GREEN AGAR OF EDEL & KAMPELMACHER
Brilliant Green agar của Edel & Kampelmacher là môi trường chọn lọc để phân lập Salmonella trong thực phẩm bao gồm các sản phẩm sữa.
Môi trường này cũng có thể được sử dụng làm môi trường phân lập thứ hai trong các phương pháp chuẩn hóa khác nhau để phát hiện Salmonella spp.
Quy cách đóng gói:
Môi trường bột khô
BK091HA – Chai 500g
BRILLIANT GREEN AGAR OF KRISTENSEN
Brilliant Green Agar of Kristensen là một môi trường chọn lọc cao dùng để phân lập salmonella, ngoại trừ Salmonella Typhi trong sản phẩm thực phẩm có nguồn gốc từ động vật.
Brilliant Green Agar cũng có thể được sử dụng làm môi trường thứ hai được lựa chọn trong các tiêu chuẩn chuẩn hóa cho nghiên cứu và phát hiện Salmonella
Quy cách đóng gói:
Môi trường bột khô
BK071HA- Chai 500g
BRILLIANT GREEN BILE BROTH (BGBB)
Brilliant Green Bile Broth (BGBB) dùng để phát hiện và định lượng coliform, coliform chịu nhiệt trong thực phẩm, nước. Nó cũng có thể được dùng để định lượng coliform trong các sản phẩm từ sữa và kem đông lạnh.
Thành phần môi trường theo tiêu chuẩn NF ISO 4831, NF ISO 4832, NF T90-413 và PR NF T90-413.
Quy cách đóng gói:
Môi trường chuẩn bị sẵn:
BM01108 – 50 lọ x 10ml (nồng độ đơn, có sẵn ống Durham)
Môi trường bột khô:
BK002HA – Chai 500g
BROMOCRESOL PURPLE (BCP) LACTOSE AGAR
Bromocresol Purple (BCP) Lactose Agar là một môi trường không chọn lọc để phát hiện và phân lập Enterobacteriaceae. Nó được dùng để xác nhận coliform trong tiêu chuẩn T90-425, cho kiểm tra vi sinh bể chứa và chai dùng trong ngành sản xuất đóng chai.
Quy cách đóng gói:
Môi trường khan
BK023HA – Chai 500g
BROMOCRESOL PURPLE LACTOSE BROTH
Môi trường Lactose Bromocresol Purple (BCP) được sử dụng làm môi trường tăng sinh để định lượng coliforms và coliforms chịu nhiệt trong nước.
Quy cách đóng gói:
BK119HA – Chai 500g
BRYANT & BURKEY BROTH WITH RESAZURIN (MODIFIED BERGERE)
Bryant and Burkey Broth with Resazurin (được cải tiến bởi Bergère) được sử dụng để đếm các bào tử Clostridium lên men lactate trong sữa và các sản phẩm từ sữa.
Quy cách đóng gói:
BK141HA – Chai 500g
BK141GC – Thùng 5kg
BUFFERED PEPTONE BROTH WITH SODIUM CHLORIDE (PH 7,0)
Buffered Peptone Broth với Sodium chloride pH 7.0 là một chất pha loãng được sử dụng để chuẩn bị các dung dịch ban đầu, thể huyền phù tan trong nước hoặc không tan trong nước (không phải lipid) của dược phẩm. Môi trường cũng sử dụng để rửa màng trong các phương pháp lọc nhằm đếm vi khuẩn, nấm men và nấm mốc trên bề mặt môi trường thạch thích hợp.
Dung dịch pha loãng có thể được sử dụng trong các phương pháp phân tích vi sinh trong mỹ phẩm.
Quy cách đóng gói:
Môi trường bột khô
BK128HA- Chai 500g
BUFFERED PEPTONE WATER
Buffered Peptone Water là một chất pha loãng thông dụng được sử dụng trong nhiều thí nghiệm và tiêu chuẩn bao gồm chuẩn bị mẫu, chuẩn bị các chất pha sẵn và dãy pha loãng mẫu (theo tiêu chuẩn ISO 6887).
Môi trường này cũng được sử dụng để tiền tăng sinh Salmonella và Cronobacter sakazakii, bằng cách phục hồi các hệ vi khuẩn từng trải qua các phương pháp xử lý như: sấy khô, khử trùng theo phương pháp Pasteur, hoạt động của chất khử trùng, tăng áp suất thẩm thấu và nồng độ acid (NF EN ISO 6579-1, ISO 22964…).
Quy cách đóng gói:
Môi trường khan (25,5 g/L):
BK018HA – Chai 500g
BK018GC – Thùng 5kg
Môi trường khan (20 g/L):
BK131HA – Chai 500g
BK131GC – Thùng 5kg
Môi trường pha sẵn:
BM05608 – 50 ống x 9mL
BM01008 – 10 lọ x 225 mL vials
BM05708 – 10 lọ x 90 mL
BM13108 – 3 túi dẻo x 3L
BM13208 – 2 túi dẻo x 5L
BM21408 – 40 túi dẻo x 5L
BUFFERED PEPTONE WATER
Buffered Peptone Water là một chất pha loãng sử dụng chung cho nhiều hoạt động bao gồm chuẩn bị mẫu, pha loãng (theo tiêu chuẩn ISO 6887).
Môi trường này cũng được sử dụng để tiền tăng sinh Salmonella và Cronobacter sakazakii, bằng cách cho phép hồi phục các vi sinh vật đã trải qua nhiều tổn thương trong các hoạt động như sấy khô, tác động chất bảo quản, áp suất thẩm thấu cao và độ chua cao (NF EN ISO 6579-1, ISO 22964 …).
Quy cách đóng gói:
Môi trường chuẩn bị sẵn:
BM05608: 50 ống x 9mL
BM01008: 10 lọ x 225 mL
BM05708: 10 lọ x 90 mL
BM13108: 3 túi x 3 lít
BM13208: 2 túi x 5 lít
BM21408: 40 túi x 5 lít
Môi trường bột khô
BK131HA- Chai 500 g
BK131GC – Thùng 5kg
BUTTIAUX BROGNIART HYPERSALTED BROTH
Buttiaux-Brogniart Hypersalted Broth là một môi trường tăng sinh nồng độ đôi (double strength) đối với việc phát hiện Staphylococcus aureus trong thực phẩm, đặc biệt là trong gelatin dùng cho thực phẩm và các sử dụng khác.
Quy cách đóng gói:
Môi trường bột khô
BK081HA – Chai 500g
CETRIMIDE AGAR
Cetrimide Agar là môi trường chọn lọc để phân lập và định lượng Pseudomonas aeruginosa trong các mẫu sinh học có nguồn gốc động vật và trong các sản phẩm dược phẩm và mỹ phẩm.
Thành phần môi trường theo Dược điển Hoa Kỳ và NF EN ISO 22717.
Quy cách đóng gói:
Môi trường chuẩn bị sẵn:
BM18408 – 100ml x10 chai
Môi trường bột khô:
BK049HA- Chai 500g
CFC AGAR
CFC Agar là môi trường chọn lọc để định lượng Pseudomonas spp. thường gây ô nhiễm thịt và các sản phẩm gia cầm đông lạnh
Thành phần chính đáp ứng tiêu chuẩn NF EN ISO 13720 – định lượng Pseudomonas giả định trong thịt và các sản phẩm từ thịt.
Quy cách đóng gói:
Môi trường chuẩn bị sẳn (không có cetrimide, fucidin và cephalosporin):
BM09608 – 10 ống x 200mL
Môi trường bột khô (không có cetrimide, fucidin và cephalosporin):
BK118HA – Chai 500g
CFC Selective Supplement (cetrimide, fucidin và cephalosporin):
BS02208 – 10 ống x 500mL
CHLORAMPHENICOL GLUCOSE AGAR
Chloramphenicol Glucose Agar được dùng để phát hiện nấm men nấm mốc trong thực phẩm.
Thành phần môi trường theo tiêu chuẩn NF V08-059, ISO 6611 và NF EN 15789.
Quy cách đóng gói:
Môi trường chuẩn bị sẵn:
BM02108 – 100 mLx10 chai
BM07908 – 200 mLx 10 chai
Môi trường bột khô:
BK007HA – Chai 500g
CHLORAMPHENICOL SELECTIVE SUPPLEMENT 50 MG
Chloramphenicol Selective Supplement 50 mg ức chế sự phát triển của hầu hết các vi khuẩn, thường được bổ sung vào các môi trường nuôi cấy nấm men nấm mốc.
Quy cách đóng gói:
BS02108 – 10 lọ
CHROMOGENIC COLIFORM AGAR (CCA)
Chromogenic Coliform agar (CCA) được sử dụng để phát hiện và đếm Escherichia coli và vi khuẩn Coliform trong nước với lượng vi khuẩn thấp (tổng số khuẩn lạc dưới 100). Có thể là nước uống, nước bể bơi đã khử trùng, hoặc nước đã qua xử lý.
Thành phần môi trường theo tiêu chuẩn ISO 9308-1: 2014.
Dễ dàng sử dụng, khuẩn lạc đặc trưng, phân biệt E. coli (khuẩn lạc màu xanh) và Coliform không phải E.coli (khuẩn lạc màu hồng)
Quy cách đóng gói:
Môi trường đổ đĩa sẵn:
BM18208 – 20 đĩa phi 90mm
Môi trường bột khô
BK204HA – chai 500g
CHROMOGENIC CRONOBACTER ISOLATION AGAR (CCI agar)
CCI Agar được sử dụng để phát hiện Cronobacter spp. trong thực phẩm và thức ăn chăn nuôi. Nó cũng được sử dụng để kiểm soát các mẫu môi trường sản xuất.
CCI Agar đặc biệt được sử dụng để phát hiện Cronobacter sakazakii và Cronobacter spp. trong sữa bột, các sản phẩm khô và các thành phần của chúng có trong thức ăn dành cho trẻ nhỏ.
Thành phần môi trường theo tiêu chuẩn NF EN ISO 22964.
Quy cách đóng gói:
Môi trường đổ đĩa sẵn:
BM15408 – 20 đĩa phi 90mm
Môi trường bột khô
BK200HA – chai 500g
CN AGAR FOR PSEUDOMONAS
Định lượng Pseudomonas Aeruginosa trong nước
CN Agar for Pseudomonas là một môi trường chọn lọc để phân lập và định lượng Pseudomonas aeruginosa trong nước đóng chai, bể bơi và nước sinh hoạt.
Thành phần môi trường theo tiêu chuẩn NF EN ISO 16266 và NF T90-421 để phân tích nước.
COAGULASE RABBIT PLASMA (HUYẾT TƯƠNG THỎ ĐÔNG KHÔ)
Huyết tương thỏ được thu hồi qua EDTA và đông khô được sử dụng để phát hiện staphylocoagulase.
BR00208: 10 lọ/ hộ (20 phản ứng/ lọ)
COLUMBIA AGAR
Columbia Agar (CA) là môi trường dinh dưỡng cao sử dụng cho tăng trưởng và phân lập môt số lượng lớn các loài vi sinh, đặc biệt là các loài khó tính như : streptococci và pneumococci trong mẫu động vật. Khi máu, các nhân tố chọn lọc hoặc tác nhân thúc đẩy tăng trưởng được thêm vào, môi trường này có thể được dùng để chuẩn bị một phổ rộng các môi trường thích hợp cho mục đích sử dụng cụ thể.
Quy cách đóng gói:
Môi trường khan:
BK019HA – Chai 500g
COMPASS® BACILLUS CEREUS AGAR / COMPASS® BACILLUS PLUS AGAR
COMPASS® Bacillus cereus Agar là một phương pháp được sử dụng để phát hiện và định lượng Bacillus cereus giả định trong các thực phẩm và thức ăn chăn nuôi.
Phương pháp COMPASS® Bacillus cereus Agar và COMPASS® Bacillus Plus Agar được chứng nhận AFNOR theo quy trình xác nhận giá trị sử dụng phương pháp ISO 16140-2 2016.
Phương pháp phát hiện, định lượng Bacillus cereus giả định trong 24 giờ mà không cần khẳng định.
Khuẩn lạc đặc trưng màu xanh, dễ dàng đọc kết quả.
COMPASS® CC AGAR
COMPASS® cc Agar cho phép đếm trực tiếp Escherichia coli và coliforms trong nước bằng phương pháp màng lọc trong 24 giờ mà không cần các thử nghiệm xác nhận điển hình như phát hiện oxidase hoặc sản xuất indole từ tryptophan.
COMPASS® cc Agar phù hợp để kiểm nghiệm nước đã qua xử lý, nước uống có mật độ vi khuẩn thấp hoặc các nguồn nước bị ô nhiễm có chứa nồng độ vi khuẩn gây nhiễm cao.
COMPASS® ECC AGAR
Chromogenic Compass Ecc Agar là môi trường chọn lọc dùng để định lượng đồng thời Coliform và E. coli mà không cần khẳng định trong thực phẩm và thức ăn chăn nuôi.
Dễ dàng sử dụng, khuẩn lạc đặc trưng, phân biệt E. coli (khuẩn lạc màu xanh) và Coliform (khuẩn lạc màu hồng).
Môi trường cho kết quả nhanh trong 24 giờ.
Quy cách đóng gói:
Môi trường bột khô
BK202HA – chai 500g
COMPASS® ENTEROBACTER SAKAZAKII AGAR
COMPASS® Enterobacter sakazakii agar được sử dụng để phát hiện Cronobacter sakazakii và Cronobacter spp. trong sữa bột, các sản phẩm khử nước và các thành phần của chúng có trong thức ăn dành cho trẻ nhỏ.
Quy cách đóng gói:
Môi trường đổ đĩa sẵn
BM12008 – 20 đĩa Petri Ø 90 mm
Môi trường bột khô:
BK188HA – chai 500 g
COMPASS® ENTEROCOCCUS AGAR
COMPASS Enterococcus Agar là môi trường chọn lọc được sử dụng để định lượng enterococcus trong thực phẩm và nước.
Môi trường cho kết quả kiểm nghiệm trong 24 giờ, không cần khẳng định.
Quy cách đóng gói:
Môi trường bột khô
BK183HA- chai 500g
Môi trường pha sẵn trong chai
BM11608- 100mlx10 chai
Môi trường đổ đĩa sẵn:
BM15708- 20 đĩa phi 90.
COMPASS® LISTERIA AGAR
COMPASS® Listeria là phương pháp nhanh được sử dụng để phát hiện và định lượng Listeria monocytogenes và Listeria spp trong thực phẩm, mẫu môi trường.
Phương pháp được chứng nhận AFNOR, xác nhận giá trị sử dụng phương pháp theo ISO 16140 : 2016. Phương pháp tham chiếu: ISO 11290-1 : 2017 và ISO 11290-2 : 2017.
Phương pháp chỉ bao gồm một bước tăng sinh chọn lọc trong Fraser ½ broth, sau đó phân lập trên COMPASS® Listeria Agar. Kết quả kiểm nghiệm: 46 giờ, khẳng định: 6 giờ.
Môi trường COMPASS® Listeria agar còn môi trường phân lập bắt buộc, sử dụng trong ISO 11290-1 và ISO 11290-2.
Sản phẩm bao gồm các code sau: BK192HA ; BS07008; BS07108
CONFIRM’ L. mono BROTH
CONFIRM’ L. mono broth là môi trường dạng lỏng dùng để phát hiện Listeria monocytogenes, được phân lập từ 1 khuẩn lạc đơn đặc trưng từ COMPASS® Listeria Agar trong trường hợp sử dụng các phương pháp thay thế cho việc phát hiện và đếm Listeria monocytogenes theo chứng nhận NF VALIDATION.
Quy cách đóng gói:
BM16208 – 18 lọ x 1mL
CONFIRM’ L.MONO AGAR
CONFIRM’ L. mono Agar là một môi trường nuôi cấy rắn được thiết kế để xác nhận họ và loài Listeria monocytogenes, được cô lập từ khuẩn lạc đặc trưng đơn lẻ từ COMPASS Listeria Agar, trong khuôn khổ phương pháp phát hiện (chứng nhận AFNOR, dưới số tham khảo BKR 23/2-11/02) và phương pháp đếm (chứng nhận AFAQ AFNOR dưới số tham khảo BKR 23/05-12/07).
Quy cách đóng gói:
Môi trường chuẩn bị sẵn trong đĩa Petri (Ø 90 mm)
BM13908 – 10 đĩa
CONFIRM’ SALMONELLA
CONFIRM ’Salmonella là một thử nghiệm ngưng kết latex cho phép xác nhận các khuẩn lạc Salmonella giả định, sau khi làm thuần.
CONFIRM ’Salmonella cũng được sử dụng để khẳng định Salmonella trong phương pháp phát hiện nhanh Salmonella -IRIS Salmonella®, không cần làm thuần, khuẩn lạc thử nghiệm được lấy trực tiếp từ môi trường IRIS Salmonella.
Phương pháp IRIS Salmonella® phát hiện Salmonella được chứng nhận bởi Chứng nhận AFNOR, Chứng nhận số N ° BKR 23/07 – 10/11 và TCVN 13370:2021.
Quy cách: BT01108: 50 test
CONTACT PCA + TTC + NEUTRALIZER
Plate Count Agar (PCA) + TTC là môi trường pha sẵn có bổ sung chất trung hòa. Môi trường nuôi cấy được sử dụng để phát hiện và đếm vi sinh vật bề mặt, giúp kiểm soát vi sinh tại các vị trí quan trọng trong sản xuất công nghiệp (ví dụ: chương trình giám sát vi sinh trên bề mặt và môi trường công nghiệp).
Quy cách đóng gói:
Môi trường sẵn sàng sử dụng: BM20608 – 20 đĩa – Ø 65mm.
CONTACT PLATE AGAR
Contact Plate Agar được sử dụng để định lượng vi sinh vật bằng cách áp tiếp xúc trực tiếp thạch lên bề mặt để kiểm tra.
Quy cách đóng gói:
Môi trường bột khô:
BK130HA- Chai 500g
CONTACT SABOURAUD WITH CHLORAMPHENICOL (SDCA) +NEUTRALIZERS
Sabouraud với Chloramphenicol Agar, được bổ sung chất trung hòa, là môi trường sẵn sàng để sử dụng.
Môi trường này được sử dụng để phát hiện và định lượng nấm men và nấm mốc có trên bề mặt bằng cách ấn lên thạch để kiểm soát các vị trí quan trọng trong công nghiệp..
Quy cách đóng gói:
Môi trường sẵn sàng sử dụng:
BM21008 – 20 đĩa petri Ø 65mm
CRONOBACTER SCREENING BROTH (CSB)
Cronobacter Screening broth là môi trường tăng trưởng chọn lọc được sử dụng để phát hiện Cronobacter spp. trong các sản phẩm và thành phần thực phẩm dùng cho người và cho động vật ăn. Nó cũng được sử dụng để kiểm nghiệm các mẫu môi trường.
Môi trường đáp ứng tiêu chuẩn NF EN ISO 22964.
Quy cách đóng gói:
Môi trường chuẩn bị sẵn:
BM15508 – 50 ống x 10mL
CYSTINE LACTOSE ELECTROLYTE DEGICIENT (CLED)
Cystine Lactose Electrolyte Deficient (CLED) agar được sử dụng để phân biệt, cô lập, đếm và phân biệt các vi khuẩn đường tiết niệu. Môi trường cho phép xác định định lượng các mầm bệnh tiết niệu bao gồm cả Proteus.
Quy cách đóng gói:
Môi trường khan :
BK020HA – Chai 500g
DESOXYCHOLATE (0.1%) LACTOSE AGAR
Desoxycholate (0,1%) Lactose Agar là một môi trường chọn lọc để định lượng vi khuẩn coliform trong sữa, sản phẩm sữa và các sản phẩm thực phẩm khác. Môi trường cũng được đề nghị để phân lập và nuôi cấy vi khuẩn Shigella.
Quy cách đóng gói:
Môi trường bột khô:
BK062HA – Chai 500g
DESOXYCHOLATE LACTOSE AGAR
Desoxycholate Lactose Agar là một môi trường chọn lọc để định lượng vi khuẩn coliform trong sữa, sản phẩm sữa và các sản phẩm thực phẩm khác. Môi trường cũng được đề nghị để phân lập và nuôi cấy vi khuẩn Shigella.
Quy cách đóng gói:
Môi trường bột khô:
BK065HA – Chai 500g
DICHLORAN GLYCEROL (DG 18) AGAR
Dichloran Glycerol (DG 18) Agar được dùng để định lượng nấm men và nấm mốc phát triển trong các sản phẩm với hoạt độ nước thấp (aw <0,95). Môi trường được ứng dụng cụ thể cho việc định lượng và phân lập nấm mốc xerophilic (được tìm thấy trong các sản phẩm khử nước hoặc cực kỳ khô như thực phẩm ngọt hoặc mặn, trái cây sấy khô, ngũ cốc, bánh ngọt và bánh quy, bột mì và thịt hoặc cá khô). Môi trường hỗ trợ cho sự tăng trưởng có kiểm soát kích thước và chiều rộng của khuẩn lạc nấm mốc và nấm men, vì thế đếm dễ dàng và chính xác hơn.
Thành phần môi trường theo tiêu chuẩn NF V08-036 & NF ISO 21527-2.
Quy cách đóng gói:
Môi trường chuẩn bị sẵn (có Glycerol)
BM10908 – 10 chai x 100mL
Môi trường bột khô ( không có Glycerol )
BK170HA – Chai 500 g
DICHLORAN ROSE BENGAL CHLORAMPHENICOL (DRBC) AGAR
Dichloran Rose Bengal Chloramphenicol (DRBC) Agar dùng để định lượng các loại nấm men và nấm mốc phát triển trong các sản phẩm dùng cho người và động vật có hoạt độ nước aw lớn hơn 0,95
Môi trường này không được dùng để định lượng bào tử nấm mốc
Thành phần môi trường đáp ứng tiêu chuẩn NF EN ISO 21527-1.
Quy cách đóng gói:
Môi trường chuẩn bị sẵn
BM14208 – 10 lọ x 200mL
Môi trường bột khô
BK198HA – Chai 500 g
DIPOTASSIUM HYDROGENPHOSPHATE SOLUTION
Dung dịch Dipotassium hydrogenphosphate là chất pha loãng được sử dụng để kiểm soát vi sinh vật của phô mai, sữa sấy lăn, sữa lên men, caseinates, dried acid whey và kem chua.
Quy cách đóng gói:
Môi trường pha sẵn:
BM19308 – 2 túi 5 L
DRIGALSKI LACTOSE AGAR
Drigalski Lactose agar được sử dụng để phân lập chọn lọc Enterobacteriaceae. Nó cho phép phân biệt vi khuẩn theo khả năng lên men đường lactose trong các mẫu thực phẩm, dược phẩm, mỹ phẩm và thú y.
Quy cách đóng gói:
BK036HA – Chai 500g
E.M.B AGAR
E.M.B Agar, ban đầu được Levine khuyến nghị sử dụng để phân lập và xác định vi khuẩn đường ruột (đặc biệt là Escherichia coli và Enterobacter aerogenes) trong các sản phẩm dược phẩm, mỹ phẩm và thực phẩm cũng như nước. Nó cũng được sử dụng như một phương tiện xác nhận Escherichia coli trong các sản phẩm mỹ phẩm.
Thành phần tuân theo tiêu chuẩn NF EN ISO 21150
Quy cách đóng gói:
Môi trường bột khô:
BK056HA- Chai 500g
EASY STAPH AGAR
EASY STAPH là một phương pháp thay thế để định lượng Staphylococci dương tính với coagulase (bao gồm cả S. hyicus và S. intermedius) trong các sản phẩm thực phẩm, thức ăn chăn nuôi và trong các mẫu môi trường.
Không cần khẳng định, phương pháp này cho phép đếm số tụ cầu gây bệnh trong 22 giờ thay vì 48 giờ thông thường trong trường hợp của phương pháp tiêu chuẩn NF EN ISO 6888-2.
Phương pháp này được chứng nhận NF VALIDATION, theo Chứng nhận N ° BKR 23/10 – 12/15.
EC BROTH
EC Broth (viết tắt của Escherichia coli) là một môi trường chọn lọc được sử dụng để khẳng định E.coli trong mẫu nước, sữa và thực phẩm cũng như động vật giáp xác.
Thành phần môi trường theo phương pháp chuẩn của định lượng E.coli giả định, kỹ thuật MPN (NF ISO 7251).
Quy cách đóng gói:
Môi trường bột khô
BK162HA – Chai 500 g
EE BROTH MOSSEL
EE Broth chứa muối mật, Brilliant gree và Glucose, được đề xuất bởi Mossel, là một môi trường tăng sinh chọn lọc để định lượng Enterobacteriaceae bằng phương pháp MPN trong thực phẩm, động vật và các sản phẩm môi trường.
Nó cũng được sử dụng trong Dược điển để phát hiện vi khuẩn Gram âm kháng muối mật.
Thành phần môi trường theo Dược điển Châu Âu.
Quy cách đóng gói:
Môi trường bột khô
BK127HA- Chai 500g
ELLIKER BROTH
Elliker Broth được tổng hợp theo công thức của Elliker, Anderson và Hannesson, có các yếu tố dinh dưỡng cần thiết cho sự phát triển của lactobacilli và liên cầu khuẩn lactic (bao gồm cả Lactococcus) trong các sản phẩm từ sữa.
Quy cách đóng gói:
Môi trường bột khô:
BK054HA – Chai 500g
ETHYL VIOLET AZIDE BROTH
Ethyl Violet azide Broth (còn được gọi là canh Litsky) được sử dụng để khẳng định các phát hiện và định lượng fecal Streptococci (enterococci) trong nước uống và nước thải, thực phẩm đông lạnh và các sản phẩm thực phẩm khác bằng phương pháp xác suất lớn nhất MPN. Quá trình liên quan đến hai giai đoạn:
– Thử nghiệm giả định trong azide Dextrose Broth (Rothe)
– Khẳng định trong Ethyl Violet azide Broth (Litsky).
Quy cách đóng gói:
Môi trường bột khô:
BK061HA – Chai 500g
EUGON LT SUP BROTH
Eugon LT SUP broth được sử dụng làm chất pha loãng trung hòa và môi trường tăng sinh vi khuẩn trong mỹ phẩm.
FRASER BROTH (BASE II)
Fraser Broth được dùng để tăng sinh chọn lọc và phân biệt (canh tăng sinh thứ cấp) của Listeria monocytogenes và của Listeria spp. trong sản phẩm thực phẩm, theo tiêu chuẩn NF EN ISO 11290-1.
Môi trường này cũng được sử dụng trong phương pháp nhanh để phát hiện và định lượng Listeria monocytogenes hoặc Listeria spp.
Quy cách đóng gói:
Môi trường pha sẵn
BM01608 – 10 lọ x 225mL
BM13308 – 3 túi x 3L
BM13408 – 2 túi x 5L
BM18808 – 40 túi x 5L ( carton )
Môi trường bột khô
BK133HA – Chai 500 g
BK133GC – Thùng 5 kg
Chất bổ sung
BS03108- 10 lọ, mỗi lọ bổ sung 500ml môi trường
FREASER BROTH
Fraser Broth thường được sử dụng là môi trường tăng sinh thứ cấp của Listeria monocytogenes và Listeria trong thực phẩm theo tiêu chuẩn NF EN ISO 11290-1.
Quy cách đóng gói:
Môi trường bột khô (không chứa ferric ammonium citrate):
BK115HA – Chai 500g
GENTAMICIN 25 MG SELECTIVE SUPPLEMENT
Gentamicin 25 mg Selective Supplement is được khuyến nghị để cải thiện khả năng phân lập nấm men và nấm gây bệnh trong các mẫu lâm sàng.
Quy cách đóng gói:
BS00908 – 10 lọ
GIOLITTI & CANTONI BROTH WITH TWEEN 80 (BASE)
Giolitti và Cantoni Broth với Tween 80 là một môi trường tăng sinh chọn lọc để phát hiện và định lượng (đặc biệt là ở số lượng thấp) staphylococci dương tính coagulase trong thực phẩm. Môi trường được sử dụng trong phương pháp MPN
Thành phần môi trường theo tiêu chuẩn NF EN ISO 6888-3.
Quy cách đóng gói:
Môi trường chuẩn bị sẳn (không có potassium tellurite)
BM11008 – 50 ống x 10 mL (môi trường nồng độ đơn)
BM11108 – 50 ống x 10 mL (môi trường nồng độ đôi)
Môi trường bột khô (không có potassium tellurite):
BK159HA – Chai 500 g
GLUCOSE AGAR
Glucose agar là môi trường để phát hiện quá trình lên men glucoza (có hoặc không sinh khí) như một phép thử xác định Enterobacteriaceae hoặc Pseudomonas spp.
Quy cách đóng gói:
Môi trường pha sẵn
BM09908 – 50 ống x10 mL
GLUTAMATE BROTH
Glutamate Broth được sử dụng để định lượng E. coli dương tính với β-glucuronidase trong các sản phẩm thực phẩm bằng kỹ thuật MPN.
Nó được khuyến nghị sử dụng khi các các vi sinh vật ở trạng thái dưới mức tối ưu do stress với các yếu tố như: đóng băng, thiếu nước, các chất kháng sinh hoặc nồng độ muối cao.
Quy cách đóng gói:
Môi trường bột khô
BK186HA -Chai 500 g
GVPC AGAR FOR LEGIONELLA
GVPC agar for Legionella được sử dụng để đếm, phân lập và nuôi cấy các loài Legionella trong nước sạch (nước nóng sản xuất, nước nóng vệ sinh, bể bơi…) và nước bẩn (nước công nghiệp, tháp giải nhiệt…).
Thành phần môi trường theo tiêu chuẩn NF T90-431 và NF EN ISO 11731.
Quy cách đóng gói:
BM07108 – 20 đĩa Petri Ø 90 mm
BM22708 – 120 đĩa Petri Ø 90 mm
HALF FRASER BROTH
Half Fraser Broth được sử dụng để tăng sinh có chọn lọc và phân biệt (canh thang tăng sinh sơ cấp) của Listeria monocytogenes và của Listeria spp. trong các sản phẩm thực phẩm theo Tiêu chuẩn NF EN ISO 11290-1.
Môi trường này cũng được sử dụng trong các phương pháp nhanh thay thế để phát hiện và định lượng Listeria monocytogenes hoặc Listeria spp.
HEKTOEN ENTERIC AGAR
Hektoen Enteric Agar là một môi trường chọn lọc để phân lập và phân biệt enterobacteria gây bệnh từ các mẫu sinh học có nguồn gốc động vật, mẫu nước, các sản phẩm sữa và thực phẩm. Nó cũng được dùng trong thú y để phát hiện Salmonella trong động vật (NF U47-102). Môi trường được khuyến nghị để phát hiện Shigella, trong vi sinh thực phẩm (NF EN ISO 21567).
Hektoen Enteric agar cũng có thể được dùng như môi trường lựa chọn thứ hai trong phương pháp tiêu chuẩn để phát hiện Salmonella.
Quy cách đóng gói:
Môi trường bột khô:
BK067HA – Chai 500g
IRIS SALMONELLA AGAR
IRIS SALMONELLA AGAR là môi trường phát hiện nhanh Salmonella trong vòng 37 giờ, khẳng định trong 2 phút.
Phương pháp được chứng nhận AFNOR và tiêu chuẩn Việt Nam (TCVN 13370:2021) về Vi sinh vật trong chuỗi thực phẩm – Phát hiện nhanh Salmonella spp. sử dụng thạch IRIS Salmonella
Phát hiện tất cả các Salmonella di động và không di động bao gồm cả các loài và kiểu huyết thanh không điển hình.
Khuẩn lạc đặc trung màu đỏ hồng.
Phương pháp đơn giản: 1 broth, 1 plate.
Mã sản phẩm: Môi trường bột khô 500g _BK212HA; Chất bổ sung chọn lọc_ BS07708
IRON SULFITE AGAR ISO 15213-1: 2023
Môi trường Iron Sulfite (ISA) (ISO 15213-1) được khuyến nghị để định lượng Clostridium spp khử sulfite.
Thành phần đáp ứng tiêu chuẩn NF EN ISO 15213-1: 2023
Quy cách đóng gói:
- Môi trường bột khô: BK239HA – Chai 500g
- Môi trường pha sẵn: BM23508 – 10 chai x200mL
KF STREPTOCOCCUS AGAR (BASE)
KF (Kenner Fecal) Streptococcus Agar là một môi trường chọn lọc được sử dụng để phân lập và định lượng enterococci trong các sản phẩm thực phẩm bằng cách sử dụng các kỹ thuật đếm khuẩn lạc trên các đĩa Petri.
Nó cũng được sử dụng trong tiêu chuẩn về thành phần của men axit lactic trong các sản phẩm sữa (ISO 27205), để phát hiện enterococci như là vi sinh vật gây nhiễm.
Quy cách đóng gói:
Môi trường bột khô
BK132HA – Chai 500 g
TTC 50 mg Supplement
BS02708 – 10 lọ
KING B AGAR
King B Agar cho phép sản xuất fluoresceine (hoặc pyoverdin), một sắc tố màu vàng lục phát huỳnh quang dưới ánh sáng cực tím ở một số chủng Pseudomonas. Môi trường được sử dụng chủ yếu trong phân tích nước để phát hiện và phân biệt Pseudomonas aeruginosa, chúng tạo ra sắc tố đặc trưng trong khi các loài Pseudomonas khác thì không.
Thành môi môi trường theo tiêu chuẩn NF EN ISO 16266.
Quy cách đóng gói:
Môi trường chuẩn bị sẵn
BM10508 – 7 ống x 7mL
KLIGLER IRON AGAR (KIA)
Kligler Iron Agar được dùng để định danh Enterobacteria bằng cách phát hiện nhanh quá trình lên men Lactose và Glucose (có hoặc không có sự tạo khí), cũng như tạo khí Hydro sunfua.
Quy cách đóng gói:
Môi trường bột khô:
BK034HA-Chai 500g
LACTOSE BROTH
Lactose Broth chủ yếu được sử dụng như một môi trường tăng sinh để phát hiện Escherichia coli trong mỹ phẩm. Nó cũng có thể được sử dụng để nuôi cấy các vi khuẩn Gram âm. Sử dụng ống Durham để phát hiện sự lên men của lactose.
Thành phần chính đáp ứng với tiêu chuẩn NF EN ISO 21150
Quy cách đóng gói:
Môi trường bột khô
BK082HA – Chai 500g
LACTOSE SULFITE BROTH (LS)
Lactose Sulfite Broth là môi trường khẳng định cho phép phát hiện có chọn lọ tế bào sinh dưỡng và bào tử của Clostridium perfringens trong thực phẩm và mẫu sinh học có nguồn gốc động vật mà không cần các xét nghiệm xác nhận thông thường.
Thành phần đáp ứng theo tiêu chuẩn NF EN ISO 7937, định lượng Clostridium perfringens trong vi sinh thực phẩm.
Quy cách đóng gói:
Môi trường pha sẵn
BM19208 – 7 ống x 9mL ( Durham)
Môi trường bột khô
BK140HA- Chai 500 g
LAURYLSULFATE TRYPTOSE BROTH
Laurylsulfate – tryptose broth là môi trường tăng sinh chọn lọc dùng để phát hiện và đếm coliform và Escherichia coli trong nước và thực phẩm.
Thành phần môi trường theo tiêu chuẩn NF T90-413 và NF ISO 7251.
Quy cách đóng gói:
Môi trường chuẩn bị sẵn:
BM09708- 10 mLx10 ống (nồng độ đơn, có sẵn ống Durham)
BM09808- 10 mLx 10 ống (nồng độ đôi, có sẵn ống Durham)
Môi trường bột khô:
BK010HA- Chai 500g
LECITHINE POLYSORBATE TRITON X AGAR (GELOSE EUGON LT 100)
Eugon LT 100 Agar được sử dụng để đếm tổng số vi sinh vật hiếu khí ưa nhiệt trong các sản phẩm mỹ phẩm có hoặc không có chất bảo quản. Nó cho phép hình thành các khuẩn lạc của hầu hết các vi sinh vật.
Thành phần điển hình được xác định trong tiêu chuẩn NF EN ISO 21149.
LISTERIA ENRICHMENT BROTH (LEB ACC. TO IDF)
Môi trường LEB (Listeria Enrichment Broth) theo Liên đoàn Sữa Quốc tế (IDF) được sử dụng để tăng sinh chọn lọc Listeria trong sữa và các sản phẩm từ sữa.
Quy cách đóng gói:
BK124HA – Chai 500g
LISTERIA ENRICHMENT BROTH (UVM I MODIFIED)
Listeria Enrichment Broth (UVM I MODIFIED) (University of Vermont) gồm một quá trình 2 bước, làm tăng khả năng phân lập Listeria monocytogenes trong các sản phẩm thịt (kể cả gia cầm).
Môi trường Listeria Enrichment Broth (UVM I MODIFIED) dùng tăng sinh sơ cấp Listeria.
Quy cách đóng gói:
Môi trường bột khô:
BK113HA – Chai 500g
LISTERIA ENRICHMENT BROTH (UVM I MODIFIED)
Môi trường LEB theo FDA (Cục Quản lý Thực phẩm và Dược phẩm) được sử dụng để tăng sinh có chọn lọc Listeria trong sữa, các sản phẩm từ sữa, thịt, gia cầm và các thực phẩm khác.
Quy cách đóng gói:
BK112HA – Chai 500g
M17 AGAR
M17 Agar được sử dụng để định lượng lactococci (đặc biệt là Lactococcus lactis) trong các sản phẩm sữa. Nó cũng được sử dụng để nghiên cứu sự nhạy cảm của những loài này với thực khuẩn. Nó thích hợp để việc định lượng Streptococcus ưa nhiệt trong sữa chua tự nhiên, sữa chua có hương vị và sữa chua trái cây.
Thành phần điển hình tương ứng với thành phần được trong tiêu chuẩn FIL-IDF 149A và ISO 7889.
Quy cách đóng gói:
Môi trường bột khô
BK088HA – Chai 500g
M17 BROTH
M17 Broth là môi trường sử dụng để tăng sinh và đếm khuẩn lạc của lactic Steptococcus (lactococci) trong sữa và các sản phẩm từ sữa. Môi trường này thuận lợi cho việc tăng sinh các chủng lactic đột biến không có khả năng lên men và Lactococcus Lactics (một chủng khó tính).
Quy cách đóng gói:
BK012HA- Chai 500g
MACCONKEY AGAR
MacConkey Agar là một môi trường chọn lọc để phân lập enterobacteria trong nước, thực phẩm, dược phẩm và các mẫu sinh học có nguồn gốc động vật và mỹ phẩm.
Thành phần môi trường theo Dược Điển châu Âu và trong tiêu chuẩn NF EN ISO 21567 và NF EN ISO 21150.
Quy cách đóng gói:
Môi trường chuẩn bị sẵn:
BM18008- 100ml x10 chai
Môi trường bột khô:
BK050HA- Chai 500g
MACCONKEY BROTH PURPLE
MacConkey Broth Purple được mô tả trong Dược điển Hoa Kỳ phát hiện Escherichia coli trong sản phẩm không tiệt trùng.
Môi trường cũng có thể được sử dụng làm để phát hiện vi khuẩn coliform trong nước, sữa và hải sản (hàu).
Quy cách đóng gói:
Môi trường bột khô
BK107HA – Chai 500g
BM18108 – 2 túi x 5 L
MACCONKEY SORBITOL (CT-SMAC) AGAR
MacConkey Sorbitol (CT-SMAC) Agar là môi trường chọn lọc được sử dụng để phân lập và phân biệt Escherichia coli O157 trong nước, sữa, các sản phẩm thịt bò và các chế phẩm thực phẩm khác.
Quy cách đóng gói:
Môi trường bột khô (không có cefixime và potassium tellurite):
BK147HA – Chai 500 g.
Cefixime-Tellurite Selective supplement:
BS03708 – 10 lọ/ hộp, mỗi lọ bổ sung cho 500mL môi trường cơ bản.
MALT EXTRACT AGAR
Malt Extract Agar dùng để định lượng nấm men nấm mốc. Nó cũng được sử dụng để phân lập và làm thuần chủng vi sinh.
Thành phần môi trường theo các tiêu chuẩn NF EN 1657; NF EN 13624; NF EN 1650 + A1.
Quy cách đóng gói:
Môi trường bột khô:
BK045HA- Chai 500g
MANNITOL SALT AGAR
Manitol Salt Agar được sử dụng để phân lập, phát hiện và định lượng Staphylococci gây bệnh trong nước như: nước hồ bơi, nước uống hoặc suối, nước khoáng. Nó cũng được dùng để phát hiện Staphylococcus aureus theo Dược điển và trong các sản phẩm mỹ phẩm.
Thành phần môi trường theo Dược điển Châu Âu và NF T90-421 cho kiểm tra nước, NF EN ISO 22718 trong mỹ phẩm.
Quy cách đóng gói:
Môi trường chuẩn bị sẵn:
BM14808 – 20 đĩa (Ø 55 mm)
Môi trường bột khô ( không có Novobiocin ):
BK030HA – Chai 500g
MEAT LIVER GLUCOSE 0.6% AGAR
Meat-Liver Glucose 0.6% Agar là môi trường được thiết kế đặc biệt để tăng sinh và phân lập vi khuẩn kị khí tăng trưởng trong phần thạch sâu của môi trường. Môi trường này còn được sử dụng để xác định các kiểu hô hấp của vi khuẩn,độ vô trùng của dược phẩm và thực phẩm đóng hộp.
Quy cách đóng gói:
Môi trường khan
BK024HA – Chai 500g
MEAT LIVER GLUCOSE AGAR
Meat Liver Glucose Agar được sử dụng để định lượng các bào tử vi khuẩn kị khí sinh sulfite trong nước. Thành phần môi trường theo tiêu chuẩn NF T90-415.
Quy cách đóng gói:
BK157HA – Chai 500 g
MEAT LIVER GLUCOSE AGAR WITH 2 G/L YEAST EXTRACT
Meat Liver Glucose Agar và 2 g/L Yeast Extract được sử dụng để đếm các bào tử vi khuẩn kỵ khí mesophilic và thermophilic trong nguyên liệu thô và trong các thành phần được sử dụng trong đóng hộp cũng như các mẫu bề mặt và nước trong quá trình đóng hộp.
Quy cách đóng gói:
Môi trường pha sẵn
BM16908 – 10 vials of 200 mL
MEAT YEAST AGAR
Meat-Yeast agar được sử dụng để đếm bào tử của của các vi sinh vật kị khí khử sulfite trong gelatin và trong các sản phẩm thực phẩm khác.
Thành phần môi trường theo tiêu chuẩn NF V59-106.
Quy cách đóng gói:
Môi trường bột khô:
BK006HA – Chai 500g
MICROPLAQUE MUD/SF
Microplate MUD / SF cho phép xác định và đếm enterococci trong nước, theo NF EN ISO 7899-1.
Quy cách đóng gói:
KIT :
BT00308 – 25 tấm giếng+ 25 nắp vô trùng.
MICROPLATE MUG/EC
Microplate MUG / EC cho phép việc xác định thực tế và đếm số Escherichia coli trong nước, theo tiêu chuẩn ISO NF EN ISO 9308-3.
MODIFIED LAURYLSULFATE TRYPTOSE VANCOMYCINE BROTH (MLST/V)
Modified Laurylsulfate Tryptose Vancomycin broth (mLST/V) là môi trường tăng sinh chọn lọc được sử dụng để phát hiện Cronobacter sakazakii trong sữa và các sản phẩm sữa, theo tiêu chuẩn ISO / TS 22964.
Quy cách đóng gói:
Môi trường pha sẵn:
BM12108 – 50 ống x 10 mL
Môi trường bột khô
BK190HA – chai 500 g
MODIFIED TRYPTO CASEIN SOY BROTH (MTSB)
Modified Tryptone Soy Broth (mTSB ) môi tăng sinh để phát hiện các kiểu huyết thanh (serotypes) gây bệnh Escherichia coIi, đặc biệt là kiểu huyết thanh O157: H7 trong thực phẩm và các mẫu có khả năng gây nhiễm khác từ nguồn gốc động vật.
Thành phần điển hình của môi trường đáp ứng tiêu chuẩn ISO 16654.
Quy cách đóng gói:
Môi trường bột khô (không có Novobiocin)
BK150HA – Chai 500 g
Novobiocin Selective Supplement:
BS05608 – 8 ống x 40mg
BS03308 – 10 ống x 10mg
MRS AGAR
MRS Agar để nuôi cấy và đếm vi khuẩn Lactobacillus trong các sản phẩm sữa và thực phẩm khác, trong các sản phẩm dùng làm thức ăn chăn nuôi.
Môi trường có thể được sử dụng để nuôi cấy các lactobacilli phát triển chậm như Lactobacillus brevis và Lactobacillus fermentum. Được axit hóa đến pH thấp, nó có thể được sử dụng để liệt kê Lactobacillus bulgaricus trong sữa chua.
Thành phần được mô tả theo tiêu chuẩn ISO 15214.
Quy cách đóng gói:
Môi trường bột khô
BK089HA – Chai 500g
BM08908- Chai 200mL x 10
MRS BROTH
MRS Broth được dùng để tăng sinh và định lượng lactobacilli trong thực phẩm. Chuyển những khuẩn lạc đã phân lập vào môi trường MRS để thu được nhiều khuẩn lạc nuôi cấy cấp 2. Môi trường có thể được sử dụng để nuôi cấy lactobacilli tăng trưởng chậm như Lactobacillus brevis và Lactobacilluc fermentum.
Quy cách đóng gói:
BK070HA – Chai 500g
BK070GC – Thùng 5kg
MSE AGAR (Mayeux, Sandine & Elliker)
Môi trường MSE agar do Mayeux, Sandine và Elliker phát triển vào năm 1962, là môi trường chọn lọc để phát hiện và định lượng Leuconostoc trong sữa, các sản phẩm từ sữa và thực phẩm ngọt.
Quy cách đóng gói:
BK087HA- Chai 500g
MSRV AGAR
Modified Semi Solid Rappaport Vassiliadis Agar (MSRV) là một môi trường chọn lọc được sử dụng để phân lập Salmonella trong sô cô la và các thực phẩm khác. Nó cũng được sử dụng rộng rãi trong sức khỏe động vật: đặc biệt với động vật có vú, gia cầm và trong các cơ sở chăn nuôi. Nó cũng được khuyến khích trong việc phát hiện Salmonellae di động trong phân động vật và trong các mẫu môi trường.
Môi trường này không được khuyến cáo cho Salmonellae bất động (Salmonella Gallinarum et Pullorum).
Thành phần môi trường theo tiêu chuẩn NF EN ISO 6579-1/A1, NF U47-100, NF U47-101 and NF U47-102.
Quy cách đóng gói:
Môi trường pha sẵn:
BM12708 – 10 chai x 200 mL
Môi trường bột khô:
BK191HA – chai 500 g
Môi trường bột khô (không có Novobiocin):
BK134HA – chai 500 g
Chất bổ sung Novobiocin:
BS03308 – 10 lọ x 10 mg
BS05608 – 8 lọ x 40 mg
MSRV MEDIUM
Modified Semi Solid Rappaport Vassiliadis Agar (MSRV) là một môi trường chọn lọc sử dụng để phân lập vi khuẩn Salmonella trong chocolate và các sản phẩm thực phẩm khác. Nó cũng được sử dụng rộng rãi trong thú y: đặc biệt với động vật có vú, gia cầm và tại các cơ sở chăn nuôi. Môi trường này còn được sử dụng để phát hiện Salmonellae di động trong phân động vật và trong các mẫu môi trường.
Môi trường này không dùng cho Salmonellae bất động (Salmonella Gallinarum và Salmonella Pullorum).
Thành phần môi trường theo tiêu chuẩn NF EN ISO 6579-1, NF U47-100, NF U47-101 và NF U47-102.
Quy cách đóng gói:
Môi trường chuẩn bị sẳn:
BM12708 – 10 lọ x 200mL
Môi trường bột khô (không có Novobiocin):
BK134HA – Chai 500 g
Novobiocin Selective Supplement
BS03308 – 10 lọ x 10mg
BS05608 – 8 lọ x 40mg
MUELLER HINTON AGAR
Mueller Hinton Agar được công nhận bởi tất cả các chuyên gia là môi trường phù hợp cho các nghiên cứu về tính nhạy cảm của vi khuẩn với kháng sinh và sulfamides. Nó thích hợp để phân lập Neisseria và là môi trường cơ bản tốt nhất để pha bị thạch máu.
Thành phần môi trường theo NF U47-106 và NF U47-107.
Quy cách đóng gói:
Môi trường bột khô:
BK048HA- Chai 500g
MUG 50 MG SUPPLEMENT
MUG 50 mg Supplement được sử dụng trong môi trường chọn lọc để kiểm soát nước, đồ uống, sản phẩm từ sữa và các sản phẩm thực phẩm khác.
Quy cách đóng gói:
BS02408 – 10 lọ/ hộp
MÜLLER & KAUFFMANN TETRATHIONATE BROTH (BASE )
Müller & Kauffmann Tetrathionate Broth là môi trường truyền thống lâu đời nhất được sử dụng để tăng sinh chọn lọc Salmonella.
Môi trường có thành phần theo tiêu chuẩn NF V 59-104.
Quy cách đóng gói:
Môi trường bột khô (không có Novobiocin):
BK135HA – Chai 500 g
Selective supplement Novobiocin 10 mg
BS03308 – 10 lọ
Selective supplement Novobiocin 40 mg
BS05608 – 8 lọ
MULLER HINTON BROTH
Mueller Hinton Broth là môi trường không chọn lọc để nuôi cấy lượng lớn các vi sinh vật có nguồn gốc khác nhau, cũng như để xác định nồng độ ức chế tối thiểu bằng phương pháp pha loãng.
Quy cách đóng gói:
Môi trường bột khô
BK108HA – Chai 500g
MULLER KAUFFMANN TETRATHIONATE NOVOBIOCIN BROTH (MKTTN)
MKTTn Broth được sử dụng làm một trong hai môi trường tăng sinh chọn lọc để phát hiện Salmonella theo phương pháp được mô tả trong tiêu chuẩn ISO 6579-1. Cùng với môi trường MSRV, nó cũng được sử dụng trong quy trình phân lập và xác định Salmonella trong môi trường chăn nuôi (NF U 47-100), trong gia cầm (NF U 47-101) và động vật có vú (NF U 47-102).
MKTTn Broth cũng được sử dụng làm môi trường tăng sinh chọn lọc thứ hai để phát hiện Salmonella trong nước theo phương pháp được mô tả trong tiêu chuẩn NF ISO 19250.
Quy cách đóng gói:
Môi trường chuẩn bị sẵn
Môi trường dạng bột (không có iodine và novobiocin)
BK169HA – Chai 500 g
Novobiocin Selective Supplement
BS03308 – 10 ống x 10mg
BS05608 – 8 ống x 40mg
MULLER KAUFFMANN TETRATHIONATE NOVOBIOCIN BROTH (MKTTN)
MKTTn Broth được sử dụng làm một trong hai môi trường tăng sinh chọn lọc để phát hiện salmonella theo phương pháp được mô tả trong tiêu chuẩn ISO 6579-1. Cùng với môi trường MSRV, nó cũng được sử dụng trong quy trình phân lập và xác định Salmonella trong môi trường chăn nuôi (NF U 47-100), trong gia cầm (NF U 47-101) và động vật có vú (NF U 47-102).
MKTTn Broth cũng được sử dụng làm môi trường tăng sinh chọn lọc thứ hai để phát hiện Salmonella trong nước theo phương pháp được mô tả trong tiêu chuẩn NF ISO 19250.
Quy cách đóng gói:
Môi trường chuẩn bị sẵn
BM07808 – 50 ống x 10mg
Môi trường bột khô (không có iodine)
BK208HA – Chai 500 g
Novobiocin Selective Supplement
BS03308 – 10 ống x 10mg
BS05608 – 8 ống x 40mg
NON ANIMAL MALT EXTRACT BROTH
Non- animal Malt Extract Broth được sử dụng cho sự phát triển nấm men và nấm mốc trong thực phẩm, mỹ phẩm và dược phẩm công nghiệp. Đảm bảo không có thành phần động vật, nó có thể được sử dụng mà không cần quan tâm đến các quy định liên quan đến các thành phần của động vật hoặc bò, khiến nó trở thành môi trường lý tưởng cho nhiều ứng dụng khác nhau.
Quy cách đóng gói:
Môi trường bột khô
BK205HA – Chai 500 g
BK205GC – Thùng 5 kg
NON ANIMAL MRS BROTH
Non MRS Broth được sử dụng chủ yếu cho sự phát triển của Lactobacilli hoặc vi khuẩn acid lactic qua lên men công nghiệp để sử dụng như giống khởi động trong các loại thực phẩm, mỹ phẩm, dược phẩm khác nhau. Bằng cách thay thế tất cả các peptones động vật với các loại tương đương không có nguồn gốc động vật, những quy định và vấn đề an toàn phát sinh từ bệnh não bong gân bò và các dạng bệnh lý liên quan có thể được loại bỏ thành công, làm cho môi trường có một công thức lên men lý tưởng cung cấp sự tăng trưởng tuyệt vời.
Quy cách đóng gói:
Môi trường bột khô
BK176HA – Chai 500 g
NON ANIMAL TRYPTIC SOY BROTH
Non Animal Tryptic Soy broth là một môi trường dinh dưỡng phổ biến có thể được sử dụng cho nhiều mục đích khác nhau. Với giá trị dinh dưỡng tuyệt vời của nó, nó hỗ trợ nuôi cấy nhiều loại vi sinh vật.
Các ứng dụng cụ thể của Non-Animal Tryptic soy broth trong các ngành công nghiệp mỹ phẩm, nông sản và dược phẩm để kiểm soát vô trùng các sản phẩm có nguồn gốc từ động vật hoặc bò.
Quy cách đóng gói:
Môi trường bột khô
BK185HA – Chai 500 g
NƯỚC CẤT VÔ TRÙNG (STERILE DISTILLED WATER)
Nước cất vô trùng là chất pha loãng được sử dụng để hoàn nguyên cho các chất bổ sung đông khô.
Quy cách đóng gói:
Môi trường pha sẵn:
BM11508 – 50 ống x 18 mL
BM19408 – 10 chai x 90 mL
NUTRIENT AGAR (2.5%)
Nutrient Agar (2.5%) được dùng chủ yếu trong việc kiểm nghiệm vi sinh nguồn nước đối với quy trình hoặc tiêu chuẩn cụ thể trong phát hiện và đếm các vi sinh mà cần đến các bước làm tinh khiết. Môi trường này cô lập tốt các khuẩn lạc.
Thành phần môi trường theo tiêu chuẩn NF EN 14569, NF EN ISO 11731 và NF EN ISO 16266.
Quy cách đóng gói:
Môi trường chuẩn bị sẵn
BM12508 – 50 ống x 18mL
NUTRIENT AGAR (2%)
Nutrient Agar 2% thường được sử dụng trong vi sinh thực phẩm, trong thử nghiệm nước và sức khỏe động vật để nuôi cấy nhiều loại vi sinh vật. Nó được sử dụng để làm thuần các khuẩn lạc, một bước quan trọng trong các quy trình khẳng định vi sinh vật. Thích hợp cho việc nuôi cấy vi khuẩn không có yêu cầu dinh dưỡng cụ thể.
Quy cách đóng gói:
Môi trường chuẩn bị sẵn
BM11808 – 50 ống x 18mL
Môi trường bột khô
BK185HA – Chai 500 g
NUTRIENT BROTH
Nutrient broth là môi trường dinh dưỡng được sử dụng cho nhiều loại vi sinh vật không yêu cầu thành phần dinh dưỡng đặc biệt.
Công thức của nó phù hợp với chỉ thị JO ngày 08/8/1972 của Pháp để phát hiện khả năng ức chế của mỹ phẩm.
Quy cách đóng gói:
Môi trường bột khô:
BK003HA – Chai 500g
OF GLUCOSE Agar
OF Glucose agar là môi trường để phát hiện quá trình lên men glucose, như một thử nghiệm xác định Enterobacteriaceae theo các tiêu chuẩn sau: NF EN ISO 21528-1 và NF EN ISO 21528-2 để phát hiện và liệt kê Enterobacteriaceae.
Quy cách đóng gói:
Môi trường pha sẵn
50 ống x 10 mL – BM19708
ORANGE SERUM AGAR
Orange Serum Agar được sử dụng để tăng trưởng, phân lập và thống kê các loại nấm men, nấm mốc và vi khuẩn chịu axit (Bacillus, lactobacilli, Leuconostoc, Streptococcus, Clostridium), là nguyên nhân gây ra sự hư hỏng trong nước ép trái cây và chất cô đặc của cam quýt. Nó cũng đã được sử dụng để kiểm soát vệ sinh của thiết bị công nghiệp được sử dụng để chuẩn bị đồ uống làm từ trái cây.
Quy cách đóng gói:
Môi trường bột khô
BK103HA – Chai 500g
OXFORD AGAR
Oxford agar là môi trường chọn lọc được sử dụng để phân biệt, phân lập và định lượng Listeria monocytogenes từ sữa và phô mai, cũng như trong các mẫu thực phẩm khác bị tạp nhiễm cao.
Môi trường còn được sử dụng làm môi trường chọn lọc thứ hai trong phương pháp phát hiện Listeria monocytogenes trong vi sinh vật thực phẩm theo NF EN ISO 11290-1.
Quy cách đóng gói:
Môi trường bột khô:
BK110HA – Chai 500g
CCCFA Selective Supplement for Oxford agar:
BS00308 – 10 ống x 500mL
OXYTETRACYCLINE GLUCOSE AGAR (OGA)
ĐỊNH LƯỢNG NẤM MEN NẤM MỐC
Oxytetracycline Glucose Agar được sử dụng để phát hiện và đếm nấm men, nấm mốc trong thực phẩm.
Thành phần môi trường theo tiêu chuẩn ISO 6611 và NF V08-059.
Palcam Agar
PHÁT HIỆN LISTERIA
PALCAM Agar là một môi trường chọn lọc được sử dụng để phân biệt, phân lập vi khuẩn Listeria monocytogenes và các vi khuẩn Listeria khác từ sữa và pho mát và các thực phẩm khác.
Môi trường có thể được sử dụng làm phương tiện thứ hai trong các phương pháp phát hiện vi khuẩn Listeria monocytogenes trong vi sinh thực phẩm (NF EN ISO 11290-1).
PANCREATIC DIGEST OF CASEIN CODEX
Pancreatic Digest of Casein Codex thì phù hợp cho việc chuẩn bị môi trường nuôi cấy cho việc kiểm soát các vi sinh thông thường. Kết hợp với pepton thịt, kết quả của nó là có nồng dộ dinh dưỡng cao và pH, nó được sử dụng trong môi trường mục đích cho sự phát triển của nấm men và nấm mốc. Nó cũng được sử dụng cho sự phát triển của vi khuẩn acid lactic và cho sự phát triển của vi khuẩn hiếu khí sinh bào tử như Bacillus.
Quy cách đóng gói:
A1402HA – Chai 500 g
A1402GC – Thùng 5 kg
PANCREATIC DIGEST OF MEAT TYPE 2
Pancreatic Digest of Meat Type 2 thì thích hợp cho môi trường nuôi cấy cho lượng lớn vi khuẩn hiếu khí và vi khuẩn kỵ khí. Nó được kiến nghị cho việc sinh bào từ ở vi khuẩn kỵ khí như Clostridium.
Quy cách đóng gói:
Môi trường bột khô
A1702HA – Chai 500 g
PAPAIC DIGEST OF SOYBEAN MEAL USP
Kết quả của việc cân bằng các lượng amino acid, carbohydrate và vitamin cần thiết, Papaic Digest of Soybean Meal USP dẫn đến sự phát triển nhanh và phong phú cảu nhiều chủng vi sinh vật, bao gồm cả nấm men và nấm mốc. Nó thường kết hợp với trypton trong môi trường Trypton Soy Broth và Trypton Suy Agar cho phát triển của các chủng vi khuẩn khó tính.
Quy cách đóng gói:
Môi trường bột khô
A1601HA – Chai 500 g
PCA WITH SKIMMED MILK
Plate Count Agar with skimmed milk được sử dụng để định lượng các vi khuẩn hiếu khí trong sữa bột và các sản phẩm từ sữa,
Nó cũng được sử dụng để định lượng vi sinh vật chịu lạnh.
Thành phần môi trường theo tiêu chuẩn NF ISO 17140, NF EN ISO 4833-1 & 2 và XP V08-034; ISO 8552, ISO 8553, ISO 14461-1 & 2 và ISO 6730 để kiểm soát các sản phẩm sữa.
Quy cách đóng gói:
Môi trường pha sẵn:
BM08608 – 10 ống x 200 mL
Môi trường bột khô
BK161HA – Chai 500 g
PENICILLIN VÀ PIMARICIN AGAR (PPA)
Penicillin và Pimaricin Agar (PPA) là môi trường chọn lọc để đếm Pseudomonas psychrotophic nhuộm màu và không nhuộm màu trong sữa, các sản phẩm sữa và trong mẫu môi trường sữa.
Thành môi môi trường đáp ứng tiêu chuẩn tiêu chuẩn XP ISO / TS 11059.
Quy cách đóng gói:
Môi trưỡng chuẩn bị sẵn trong đĩa Petri (∅ 90 mm):
BM15608 – 20 đĩa
PEPTIC DIGEST OF MEAT USP
Peptic Digest of Meat USP được sử dụng cho sự phát triển của nấm men và nấm mốc, enterobacteria, staphylococci và nhiều chủng vi sinh khác.sau kho bổ sung vào môi trường thạch máu ( Blood agar), nó là yếu tố cho sự phát triển của pneumococci, cũng như sản phẩm của sự tan máu đặc trưng. Bởi vì có chứa hàm lượng lưu huỳnh cao, nó được sử dụng cho việc phát hiện H2S.
Quy cách đóng gói:
Môi trường bột khô
A1708HA – Chai 500 g
A1708GC – Thùng 5 kg
PEPTONE WATER
Peptone water thường được sử dụng để nuôi cấy vi sinh vật không có yêu cầu tăng trưởng cụ thể. Môi trường được sử dụng cho thử nghiệm Mackenzie khẳng định Escherichia coli thông qua phản ứng indole.
Thành phần của môi trường phù hợp với tiêu chuẩn NF ISO 7251, phát hiện và đếm E.coli bằng phương pháp MPN trong vi sinh thực phẩm
Quy cách đóng gói:
Môi trường bột khô
BK084HA – Chai 500g
PHƯƠNG PHÁP CSD
Phương pháp CSD cho phép phát hiện nhanh Cronobacter spp trong các sản phẩm thực phẩm dành cho người (đặc biệt là sữa bột và nguyên liệu dành cho trẻ sơ sinh) và các sản phẩm từ môi trường sản xuất.
Phương pháp cho phép tăng sinh chọn lọc đồng thời Cronobacter spp và Salmonella spp, với chất bổ sung Salmonella Enrichment + CSD.
Phương pháp được xác nhận giá trị sử dụng theo NF EN ISO 16140-2: 2016. Phương pháp tham chiếu: EN ISO 22964 : 2017.
Thành phần môi trường theo EN ISO 22964 : 2017.
Thời gian kiểm nghiệm: 2 ngày mà không cần khẳng định.
PLATE COUNT AGAR (PCA)
Plate Count Agar có chứa glucose và yeast extract được sử dụng để đếm vi khuẩn hiếu khí trong sữa, thịt, các sản phẩm từ thịt và các sản phẩm thực phẩm khác, cũng như cho các phân tích về dược phẩm, mỹ phẩm và các nguyên liệu liên quan. Nó cũng được sử dụng để đếm các vi sinh vật psychrotrophic.
Thành phần điển hình tương ứng với tiêu chuẩn NF EN ISO 4833-1 & 2, NF ISO 17410, XP V08- 034; T90-425 và ISO 14461-1.
POTATO DEXTROSE AGAR
Potato Dextrose Agar (PDA) được khuyến nghị trong các tiêu chuẩn áp dụng cho mỹ phẩm. Nó có thể được sử dụng làm môi trường chọn lọc sau khi bổ sung cloramphenicol hoặc để thử nghiệm ứng dụng. Môi trường thích hợp cho sự phát triển của nấm men và nấm mốc
Thành phần điển hình được mô tả trong NF EN ISO 18416.
R2A AGAR
R2A (Reasoner’s 2A) Agar là một môi trường dùng để định lượng tổng số vi sinh vật hiếu khí có khả năng sống trong nước đã qua xử lý như nước tinh khiết, nước tinh khiết cao và nước để chuẩn bị tiêm.
Thành phần môi trường theo tiêu chuẩn của Dược điển Châu Âu.
Quy cách đóng gói:
Môi trường chuẩn bị sẵn
BM18308 – 10 lọ x 100mL
Môi trường bột khô
BK179HA – Chai 500 g
RAPPAPORT VASSILIADIS SOJA (RVS) BROTH
Rappaport Vassiliadis Soja (RVS) Broth được sử dụng để tăng sinh có chọn lọc Salmonella trong sữa, các sản phẩm từ sữa, sản phẩm thực phẩm khác, nước và trong các mẫu môi trường.
Thành phần điển hình tương ứng tiêu chuẩn NF EN ISO 19250, NF EN ISO 6579-1, NF U47-102 và Dược điển Châu Âu.
Quy cách đóng gói:
Môi trường chuẩn bị sẵn
BM07408 – 10 ống x 50mL
Môi trường bột khô
BK148HA – 500 g
REINFORCED CLOSTRIDIAL AGAR
Reinforced Clostridial Agar là môi trường không chọn lọc thường sử dụng để phân lập và đếm Clostridia, vi sinh vật kỵ khí khác, lactobacilli trong mẫu sinh học, sản phẩm từ sữa và thực phẩm.
Quy cách đóng gói:
Môi trường bột khô
BK090HA – Chai 500g
REINFORCED CLOSTRIDIAL BROTH
Môi trường Reinforced Clostridial Broth là một môi trường không chọn lọc được sử dụng để phát triển và đếm số lượng bào tử của tổng số Clostridia sinh khí trong các sản phẩm từ sữa, thực phẩm đóng hộp, thực phẩm bán bảo quản và các sản phẩm thực phẩm khác. Nó cũng được sử dụng để phát hiện Clostridia trong việc kiểm tra vi sinh đối với các sản phẩm không vô trùng theo Dược điển Hoa Kỳ và Châu Âu.
Thành phần điển hình được mô tả trong dược điển Hoa Kỳ và châu Âu.
Quy cách đóng gói:
Môi trường bột khô
BK094HA – Chai 500g
RHAPSODY AGAR®
RHAPSODY Agar® là môi trường chọn lọc được sử dụng để định lượng Pseudomonas spp. trong các sản phẩm thực phẩm và các mẫu môi trường.
Phương pháp này được chứng nhận NF VALIDATION theo ISO 16140-2: 2016, để đếm Pseudomonas spp. trong các sản phẩm thịt.
Phương pháp tham chiếu được sử dụng để xác nhận là tiêu chuẩn NF EN ISO 13720: 2010.
Phương pháp này cũng được chứng nhận NF VALIDATION theo ISO 16140-2: 2016, để đếm Pseudomonas spp. trong các sản phẩm sữa.
Phương pháp đã được xác nhận cho phép thống kê trong 48 ± 3 giờ mà không cần xác nhận đối với các sản phẩm thịt và sản phẩm sữa.
RINGER’S SOLUTION (1/4 STRENGTH)
Ringer’s Solution 1/4 strength là chất để chuẩn bị môi trường pha loãng được sử dụng để kiểm soát vi sinh vật trong nước, sữa, và các thực phẩm khác. Nó cũng được sử dụng rộng rãi để chuẩn bị các dung dịch pha loãng bậc mười nối tiếp.
ROGOSA AGAR
Rogosa Agar là môi trường chọn lọc dùng để định lượng Lactobacilli trong thịt, thực phẩm và các mẫu sinh học có nguồn gốc động vật.
Do nồng độ muối cao, môi trường không thích hợp để phân lập của một số Lactobacilli trong sữa như Lactobacillus delbrueckii subsp. lactis hoặc Lactobacillus delbrueckii subsp. bulgaricus.
Quy cách đóng gói:
Môi trường bột khô:
BK033HA – Chai 500g
ROSE BENGAL CHLORAMPHENICOL AGAR
Rose Bengal Chloramphenicol Agar được dùng để phân lập chọn lọc và định lượng nấm men, nấm mốc trong các sản phẩm thực phẩm, môi trường, và bất kỳ mẫu có nguồn gốc động vật có khả năng bị nhiễm khác.
Quy cách đóng gói:
Môi trường bột khô
BK151HA – Chai 500 g
SABOURAUD CHLORAMPHENICOL AGAR
Sabouraud Chloramphenicol Agar được dùng để phân lập nấm men và nấm mốc, đặc biệt khi mẫu chứa mật độ vi khuẩn cao.
Quy cách đóng gói:
Môi trường bột khô ( không có Novobiocin ):
BK027HA – Chai 500g
SABOURAUD DEXTROSE AGAR (SDA)
Sabouraud Dextrose Agar (SDA) là môi trường cổ điển được dùng để nuôi cấy, phân lập, phát hiện nấm men và nấm mốc trong test vô trùng các sản phẩm dược phẩm và mỹ phẩm. Nó cũng được dùng trong phát hiện cụ thể Candida albicans trong các sản phẩm dược.
Thành phần điển hình đáp ứng định nghĩa trong tiêu chuẩn NF EN ISO 18416, NF EN ISO 16212, NF EN ISO 11930 và trong Dược điển Châu Âu.
Quy cách đóng gói:
Môi trường bột khô:
BK025HA – Chai 500g
Môi trường đổ sẵn trong đĩa Petri (90mm):
BM17308 – 20 Đĩa
Môi trường ready-to-melt:
BM05308 – 10 ống x 200 mL
SABOURAUD DEXTROSE BROTH
Sabouraud Dextrose Broth được khuyến nghị dùng cho phát hiện Candida albicans trong các sản phẩm không vô trùng theo Dược điển. Nó cũng được dùng làm môi trường dinh dưỡng để phát triển nấm men và nấm mốc.
Thành phần môi trường theo Dược điển Mỹ và Châu Âu.
Quy cách đóng gói:
Môi trường bột khô:
BK026HA – Chai 500g
SABOURAUD DEXTROSE CHLORAMPHENICOL AGAR (SDCA)
Sabouraud Dextrose chloramphenicol Agar (SDCA) được khuyến cáo để phân lập và định lượng nấm men và nấm mốc, đặc biệt khi các mẫu bị nhiễm vi khuẩn cao. Nó cũng được sử dụng làm môi trường phân lập chọn lọc cho Candida albicans trong các sản phẩm mỹ phẩm.
Thành phần môi trường theo NF EN ISO 18416 và NF EN ISO 16212.
Quy cách đóng gói:
Môi trường đổ đĩa sẵn
BM17608 – đĩa 20 Petri Ø 90 mm
Môi trường pha sẵn
BM17208 – 10 lọ x 200 mL
SALMONELLA ENRICHMENT
Salmonella Enrichment là một công thức đặc biệt của Buffered Peptone Water, được tạo ra để phát hiện tối ưu Salmonella trong các thực phẩm và thức ăn chăn nuôi.
Salmonella Enrichment with Tween®80 được sử dụng làm môi trường tăng sinh để phân tích Salmonella các sản phẩm có hàm lượng chất béo vượt quá 20%.
Đây là môi trường được sử dụng trong tiêu chuẩn TCVN 13370:2021 về Vi sinh vật trong chuỗi thực phẩm – Phát hiện nhanh Salmonella spp. sử dụng thạch IRIS Salmonella.
SALMONELLA SHIGELLA (SS) AGAR
Salmonella-Shigella (SS) agar được sử dụng để phân lập Salmonellae và Shigellae trong phân. Nó cũng được sử dụng như môi trường phân lập thứ hai để phát hiện Samonella theo phương pháp chuẩn.
Quy cách đóng gói:
Môi trường khan :
BK022HA – Chai 500g
SELENITE CYSTINE BROTH
Selenite-cystine broth được sử dụng để tiền tăng sinh chọn lọc Salmonella trong sữa và các sản phẩm từ sữa nhưng cũng được dùng cho đặc trưng của vết nhầy tồn dư. Nó cũng được dùng trong thú y trong phát hiện Salmonella Gallinarum hoặc trong kiểm tra nước.
Thành phần môi trường theo NF U47-101 & NF U47-102 ; NF EN ISO 6579-1; NF EN ISO 19250 ; FD/CEN/TR 15215-2.
Quy cách đóng gói:
Môi trường bột khô:
BK009HA – Chai 500g
SLANETZ AND BARTLEY AGAR
Slanetz and Bartley Agar là một môi trường chọn lọc được sử dụng để đếm Enterococci đường ruột trong nước uống, đồ uống, nước thải, nước hồ bơi và các sản phẩm sinh học khác nhau có nguồn gốc động vật, bằng phương pháp màng lọc.
Thành phần theo Tiêu chuẩn NF EN ISO 7899-2 và NF T90-421.
SLANETZ AND BARTLEY AGAR
Slanetz and Bartley Agar là môi trường chọn lọc sử dụng để định lượng Enterococci trong nước uống, nước giải khác, nước thải, nước hồ bơi và các sản phẩm sinh học khác nhau có nguồn gốc từ động vật, bằng phương pháp màng lọc.
Thành phần môi trường theo tiêu chuẩn NF EN ISO 7899-2 và NF T90-421.
Quy cách đóng gói:
Môi trường chuẩn bị sẵn:
BM09408 – 20 đĩa (Ø 55 mm)
BM09408 – 120 đĩa (Ø 55 mm)
Môi trường bột khô ( Không có TTC )
BK129HA – Chai 500 g
TTC 50 mg Supplement
BS02708 – 10 x 500mL
SUGAR FREE AGAR (SFA)
Sugar Free Agar dùng để định lượng các chất gây ô nhiễm trong các sản phẩm sữa là môi trường không chứa carbohydrate được sử dụng để phát hiện và định lượng các vi sinh vật không trải qua các quá trình lên men.Cụ thể là trong quá trình chuẩn bị các sản phẩm sữa. Kết quả của việc định lượng là cung cấp một dấu hiệu về mức độ nhiễm vi sinh của mẫu được thử.
Môi trường này được dùng để định lượng các vi sinh vật gây nhiễm trong bơ, sữa lên men và pho mát tươi.
Thành phần môi trường theo tiêu chuẩn ISO 13559.
Quy cách đóng gói:
Môi trường chuẩn bị sẵn
BM12208 – 10 lọ x 100mL
Môi trường bột khô
BK126HA – Chai 500g
SYMPHONY AGAR
Symphony Agar cho phép đếm nấm men và nấm mốc trong tất cả các mẫu thực phẩm và thức ăn chăn nuôi mà không cần phụ thuộc vào hoạt độ nước.
Môi trường SYMPHONY agar được chứng nhận bởi NF VALIDATION cho việc định lượng nấm men và nấm mốc ở tất cả các mẫu thực phẩm và thức ăn chăn nuôi, tham chiếu BKR 23 / 11-12 / 18.
Môi trường này cho phép định lượng chỉ trong vòng 54 giờ.
Phương pháp đạt TCVN 13369: 2021- VI SINH VẬT TRONG CHUỖI THỰC PHẨM- ĐỊNH LƯỢNG NHANH NẤM MEN, NẤM MỐC SỬ DỤNG THẠCH SYMPHONY AGAR
SYNTHETIC SEA SALT
SYNTHETIC SEA SALT (muối biển) tổng hợp được sử dụng làm chất pha loãng để phát hiện và định lượng Escherichia coli và enterococci trong nước hồ bơi và nước bề mặt trong phương pháp sử dụng vi đĩa (phương pháp MPN) theo tiêu chuẩn ISO 9308-3 và ISO 7899-1.
Quy cách đóng gói:
BR00308 – Chai 100g
BM08808 – 50 x 18ml tubes
TCBS AGAR
Thiosulfate Citrate Bile Sucrose Agar là một môi trường chọn lọc để phân lập vi khuẩn Vibrio cholerae và Enteropathologic Vibrio khác (đặc biệt là Vibrio parahaemolyticus) trong cá, hải sản và các mẫu sinh học có nguồn gốc động vật.
Thành phần môi trường theo tiêu chuẩn NF EN ISO 21872-1.
Quy cách đóng gói:
Môi trường bột khô:
BK040HA- Chai 500g
TERGITOL 7 AGAR
Tergitol 7 Agar (NF EN ISO) được sử dụng để định lượng Escherichia coli và vi khuẩn Coliform trong nước, đặc biệt là nước uống bằng phương pháp lọc màng.
Môi trường này cũng được sử dụng để kiểm tra nước bể bơi.
Thành phần môi trường theo tiêu chuẩn: NF EN ISO 9308-1 kiểm tra nước sinh hoạt và NF T90-431 để kiểm tra nước bể bơi.
Quy cách đóng gói:
Môi trường pha sẵn
BM14708 – 20 đĩa (Ø 55 mm)
BM09308 – 120 đĩa (Ø 55 mm)
Môi trường bột khô:
BK123HA – Chai 500g
Chất bổ sung TTC 12,5 mg:
BS02608 – 10 ống
THIOGLYCOLLATE MEDIUM WITH RESAZURIN
Thioglycollate Medium with Resazurin được sử dụng để kiểm tra độ vô trùng của các sản phẩm sinh học và để nuôi cấy vi khuẩn hiếu khí, kị khí và vi khuẩn vi hiếu khí.
Môi trường này cũng được sử dụng để xác định Clostridium perfringens trong vi sinh thực phẩm.
Thành phần môi trường được định nghĩa trong Dược điển Châu Âu và trong tiêu chuẩn NF EN ISO 7937.
Quy cách đóng gói:
Môi trường khan:
BK017HA- Chai 500g
Môi trường pha sẵn:
BM08208- 10mL x 50 ống
THIOGLYCOLLATE MEDIUM WITH RESAZURIN CRISTAL
Thioglycollate Medium with Resazurin Cristal được sử dụng để kiểm tra độ vô trùng của các sản phẩm sinh học và nuôi cấy vi khuẩn hiếu khí, kỵ khí và vi hiếu khí. Công thức của môi trường tuân thủ các yêu cầu của Dược điển Châu Âu, Dược điển Hoa Kỳ và AOAC để phân tích vi khuẩn của kháng sinh và xác định tác dụng diệt bào tử của chất khử trùng. Quy trình sản xuất và sự lựa chọn nghiêm ngặt các tác nhân đông đặc mang lại sự trong suốt đặc biệt của môi trường này.
Quy cách đóng gói:
BK206GC – Thùng 5 kg
TRYPTO CASEIN SOY AGAR (TSA)
Trypto Casein Soy Agar là một môi trường dinh dưỡng phổ biến phù hợp cho nhiều mục đích sử dụng. Giá trị dinh dưỡng của TSA có thể được sử dụng cho sự phát triển và phân lập của cả vi khuẩn hiếu khí và kỵ khí và để tạo điều kiện cho sự phát triển của các vi sinh vật “khó tính” nhất. Ngoài ra, TSA (Tryptic Soy Agar) còn được sử dụng là môi trường tham chiếu để đánh giá năng suất và tiêu chí chọn lọc của tiêu chuẩn ISO 11133.
Thành phần môi trường theo Dược điển Hoa Kỳ và EU.
Quy cách đóng gói:
Môi trường pha sẵn trong đĩa petri:
BM05008- 20 đĩa
Môi trường pha sẵn trong chai:
BM01708- 100ml x 10 chai
BM04908- 200ml x 10 chai
Môi trường bột khô:
BK047HA- Chai 500g
TRYPTO CASEIN SOY BROTH (TSB)
Tryptone Soy Broth là một môi trường dinh dưỡng phổ biến phù hợp với nhiều mục đích sử dụng. Giá trị dinh dưỡng của TSB tạo điều kiện cho hầu hết các vi sinh vật khó tính. TSB được sử dụng trong nền công nghiệp dược phẩm để đáp ứng các xét nghiệm vô trùng. TSB cũng được dùng trong tiêu chuẩn kiểm soát chất lượng cho các sản phẩm mỹ phẩm, thú y.
Thành phần môi trường theo Dược điển châu Âu.
Quy cách đóng gói:
Môi trường pha sẵn trong ống nghiệm:
BM03008 – 10ml x 50 ống
Môi trường pha sẵn trong chai:
BM00908 – 100ml x 10 chai
BM17908 – 200ml x 10 chai
Môi trường bột khô:
BK046HA – Chai 500g
BK046GC – Thùng 5kg
TRYPTONE BILE-X GLUCURONATE (TBX) AGAR
TBX Agar là một môi trường chọn lọc để định lượng Escherichia coli dương tính với β-D-glucuronidase
trong các sản phẩm thực phẩm và các mẫu môi trường của khu vực sản xuất. Kết quả thu được trực tiếp
bằng cách đếm các khuẩn lạc đặc trưng sau 24 giờ ủ và không cần bước xác nhận.
Thành phần điển hình tương ứng với thành phần được xác định trong các tiêu chuẩn NF ISO16649-1,
NF ISO 16649-2 và NF EN ISO 16649-3.
Quy cách đóng gói:
Môi trường bột khô
BK146HA – Chai 500 g
BK146HM – Chai 100g
TRYPTONE SALT BROTH
Tryptone Salt Broth (TSB) là dung môi hòa tan các mẫu rắn từ thực phẩm, mỹ phẩm và các sản phẩm từ sữa trong bước chuẩn bị của quy trình kiểm nghiệm vi sinh.
Quy cách đóng gói:
Môi trường pha sẵn:
BM00808 – 9 mL x 50 ống
BM11408 – 90 mL x 10 chai
BM13508 – Túi dẻo 3L
Môi trường bột khô:
BK014HA- Chai 500g
TRYPTONE SULFITE CYCLOSERINE AGAR (TSC AGAR)
Tryptone Sulfit Cycloserine Agar được dùng để phân lập chọn lọc và định lượng Clostridium perfringens trong các mẫu nước và thực phẩm. Môi trường này thích hợp cho việc định lượng các vi khuẩn yếm khí tiêu thụ (khử) Sulfur từ thực phẩm có nguồn gốc động vật.
Thành phần môi trường theo tiêu chuẩn ISO 14189, NF EN ISO 7937 và NF V08-061.
Quy cách đóng gói:
Môi trường chuẩn bị sẵn (không có D-Cycloserine):
BM07708 – 200 mLx10 ống
BM03908 – 20 mLx50 ống
Môi trường bột khô (không có D-Cycloserine):
BK031HA – Chai 500g
D-Cycloserine lyophilisate Selective Supplement
BS00608- 500mLx10 ống
D-Cycloserine Liquid Selective Supplement:
BS09208 – 90mLx10 ống (qsp 9 Liters)
BS09408 – 50mLx1 ống (qsp 5 Liters)
TRYPTONE USP
Tryptone USP là thích hợp trong nhiều ứng dụng trong vi sinh thông thường cho việc chuẩn bị môi trường nuôi cấy. Với nồng độ tryptophan cao, nó được dùng để phát hiện sản phẩm của indole. Sự thiếu các chất lên men carbohydrate, nó bao gồm trong môi trường nghiên cứu sự lên men đường. Với tính tương thích của nó với các thành phần khác, các pepton hoặc các chiết xuất, Tryptone USP được bao gồm trong các thành phần của môi trường mục đích cho sự phát triển và đếm các vi khuẩn trong nước, sữa, các thực phẩm khác, dược phẩm và mỹ phẩm. Kết hợp với enzym tiêu hóa papaic của bột đậu nành, nó được sử dụng cho việc chuẩn bị môi trường Trypton Soy Broth và Trypton Soy Agar.
Quy cách đóng gói:
Môi trường bột khô
A1401HA – Chai 500 g
A1401GC – Thùng 5 kg
TRYPTOPHAN BROTH
Tryptophan Broth cho phép nuôi cấy vi sinh vật không có yêu cầu tăng trưởng đặc biệt. Môi trường được sử dụng để thực hiện thử nghiệm sinh indole, được sử dụng đặc biệt trong việc khẳng định Escherichia coli, Shigella và Salmonella.
Thành phần môi trường theo tiêu chuẩn NF EN ISO 9308-1, NF EN ISO 6579-1, NF EN ISO 16654.
Quy cách đóng gói:
Môi trường chuẩn bị sẵn
BM07608 – 50 ống x 3mL
Môi trường bột khô
BK163HA – Chai 500 g
TSI AGAR (ISO 6579-1)
TSI (Triple Sugar Iron) Agar được sử dụng để xác định vi khuẩn đường ruột bằng cách phát hiện nhanh quá trình lên men của lactose, glucose (có hoặc không sinh khí) và sucrose, cũng như tạo khí hydrogen sulfide.
Quy cách đóng gói:
Môi trường bột khô
BK221HA – Chai 500 g
TSN AGAR
TSN agar là môi trường dùng để phát hiện và đếm vi sinh vật sử dụng sulfur tại 46 °C có chứa trong các sản phẩm thực phẩm, đặc biệt là trong các bữa ăn đã được đóng gói sẵn.
Thành phần môi trường được Mossel đề xuất, Marschall và công sự phát triển.
Quy cách đóng gói:
BK001HA – Chai 500g
TSYEA MEDIUM
TSYEA là một môi trường phổ biến được sử dụng trong một số ứng dụng hoặc protocol. Do giá trị dinh dưỡng tuyệt vời của nó, nó thường được sử dụng để phân lập và tinh sạch vi sinh vật thu được từ môi trường chọn lọc (tức là thạch PALCAM, thạch Oxford, thạch COMPASS® Listeria Agar, v.v.) để phát hiện hoặc định lượng Listeria, và cụ thể hơn là Listeria monocytogenes theo các tiêu chuẩn hiện hành.
Thành phần môi trường theo tiêu chuẩn NF EN ISO 11290-1 và NF EN ISO 11290-2.
Quy cách đóng gói:
Môi trường chuẩn bị sẵn
BM10808 – 50 ống x 18 mL
Môi trường bột khô
BK224HA – Chai 500 g
TTC 50 MG SELECTIVE SUPPLEMENT
TTC 50 mg supplement là một chỉ số về sự phát triển của vi khuẩn. Nó được sử dụng với Slanetz và Bartley Agar (cơ sở) hoặc KF Streptococcus Agar (cơ sở) để định lượng enterococci trong nước máy, đồ uống, nước thải và các sản phẩm sinh học khác nhau, sử dụng cả kỹ thuật lọc màng và kỹ thuật định lượng cổ điển trong đĩa Petri .
Quy cách đóng gói:
BS02708 – 10 lọ/ hộp
Violet Red Bile Agar (VRBL)
Violet Red Bile Agar (VRBL) là môi trường chọn lọc được sử dụng để phát hiện và định lượng coliform và coliforms chịu nhiệt trong mẫu thực phẩm.
Thành phần môi trường theo tiêu chuẩn NF V08-050, NF V08-060 và NF ISO 4832.
Quy cách đóng gói:
Môi trường chuẩn bị sẵn
BM03408 – 10 chai x 100mL
BM03508 – 10 chai x 200mL
Môi trường bột khô
BK152HA – Chai 500 g
BK152GC – Thùng 5 kg
VIOLET RED BILE GLUCOSE AGAR (VRBG AGAR)
Violet Red Bile Glucose Agar (VRBG Agar) được tạo bởi Mossel để phát hiện và định lượng enterobacteria trong sữa, thịt, thịt lợn chế biến sẵn và các sản phẩm thực phẩm khác. Môi trường cũng được sử dụng để phát hiện vi khuẩn Gram âm, các vi khuẩn kháng muối mật trong quá trình kiểm soátt vi sinh của các các sản phẩm không vô trùng.
Thành phần môi trường theo tiêu chuẩn NF EN ISO 21528-1 & 21528-2, NF V08-054 và European Pharmacopeia.
Quy cách đóng gói:
Môi trường pha sẵn:
BM07508- 200 mLx10 chai
Môi trường bột khô:
BK011HA- Chai 500g
BK011GC- Thùng 5kg
WILKINS CHALGREN AGAR
Wilkins Chalgren Agar dùng để xác định nồng độ ức chế tối thiểu của kháng sinh đối với vi khuẩn kỵ khí bằng phương pháp pha loãng. Nó cũng có thể được sử dụng cho sự phát triển phong phú và phân lập vi khuẩn kỵ khí.
Quy cách đóng gói:
BK101HA – Chai 500g
XLD AGAR
XLD (Xylose Lysine Desoxycholate) Agar được sử dụng chủ yếu để phân lập Salmonella và Shigella trong các sản phẩm thực phẩm. Nó cũng được sử dụng để phát hiện Salmonella trong động vật, (với động vật có vú, chim và trong sản phẩm động vật môi trường) và trong nước.
Thành phần môi trường theo tiêu chuẩn NF EN ISO 6579-1, NF EN ISO 21527, NF EN ISO 19250, NF U47-100 đến 102 và FD CEN/TR 15215-2 & 15215-3.
Quy cách đóng gói:
Môi trường chuẩn bị sẵn (Ø 90 mm)
BM08708 – 20 đĩa
Môi trường bột khô
BK168HA – Chai 500 g
XLD AGAR (EP/ USP)
PHÁT HIỆN SALMONELLA
XLD (Xylose Lysine Desoxycholate) Agar thường được sử dụng để phân lập Salmonella trong dược phẩm. Thành phần môi trường tuân theo Dược phẩm EU và Hoa Kỳ.
Quy cách đóng gói: BK058HA – chai 500g
XLT4 AGAR
XLT4 (Xylose-Lysine-Tergitol 4) Agar là môi trường phân lập chọn lọc để phát hiện Salmonella, ngoại trừ Salmonella Typhi và Paratyphi.
Thành phần tuân theo tiêu chuẩn NF U47-102.
Quy cách đóng cách:
BK156HA – Chai 500g
BM03608 – 20 Đĩa petri Ø 90 mm
Tergitol 4 Selective Supplement:
BS03908 – 10 lọ
YEAST EXTRACT AGAR
Yeast Extract Agar được sử dụng để định lượng các vi sinh vật trong nước bằng cách uôi cấy và đếm các khuẩn lạc ở 36 và 22oC. Phương pháp này nhằm đo hiệu quả khả năng xử lý nước uống và trong tất cả các loại nước. Nó đặc biệt phù hợp với việc phân tích nước sử dụng cho con người bao gồm nước đóng chai, nước khoáng thiên nhiên và nước hồ bơi.
Thành phần môi trường theo các tiêu chuẩn NF EN ISO 6222 và NF T90-421.
Quy cách đóng gói:
Môi trường chuẩn bị sẵn
BM06808 – 10 ống x 200 mL
Môi trường bột khô
BK153HA – Chai 500 g
YEAST EXTRACT AGAR
Yeast extract là thành phần dinh dưỡng chủ yếu trong moi trường nuôi cấy. Nó thúc đẩy sự sinh trưởng của nhiều loại vi sinh vật, bao gồm cả nấm men và nấm mốc. Bởi vì nó chứa carbohydrate , nên nó không thích hợp cho các môi trường nghiêng cứu quá trình lên men đường.
Quy cách đóng gói:
Môi trường bột khô
A1202HA – Chai 500 g
A1202GC – Thùng 5 kg


 English
English